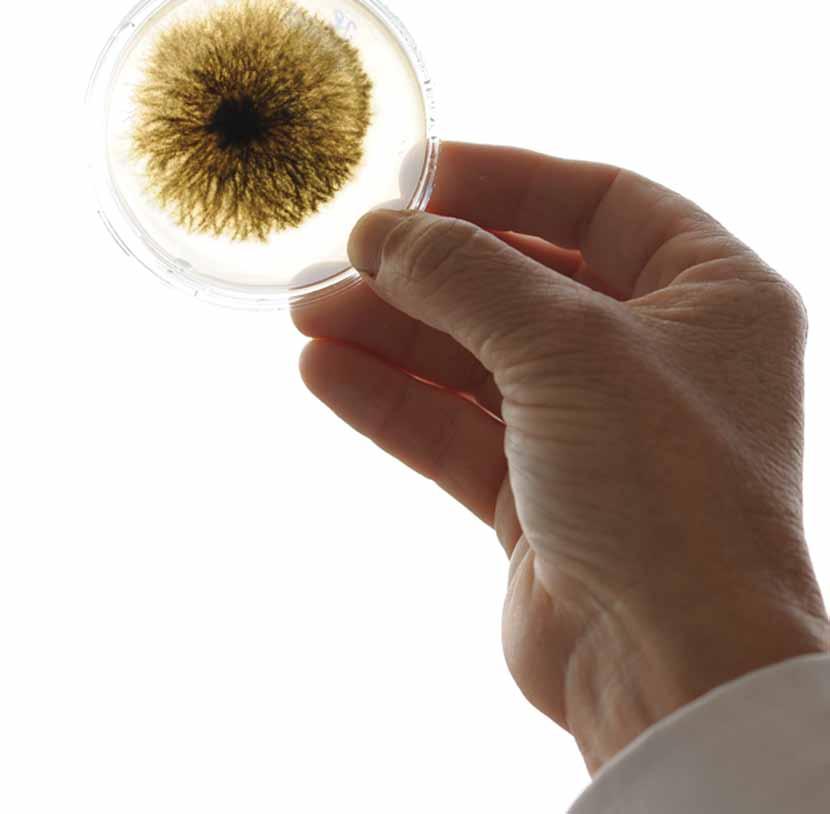
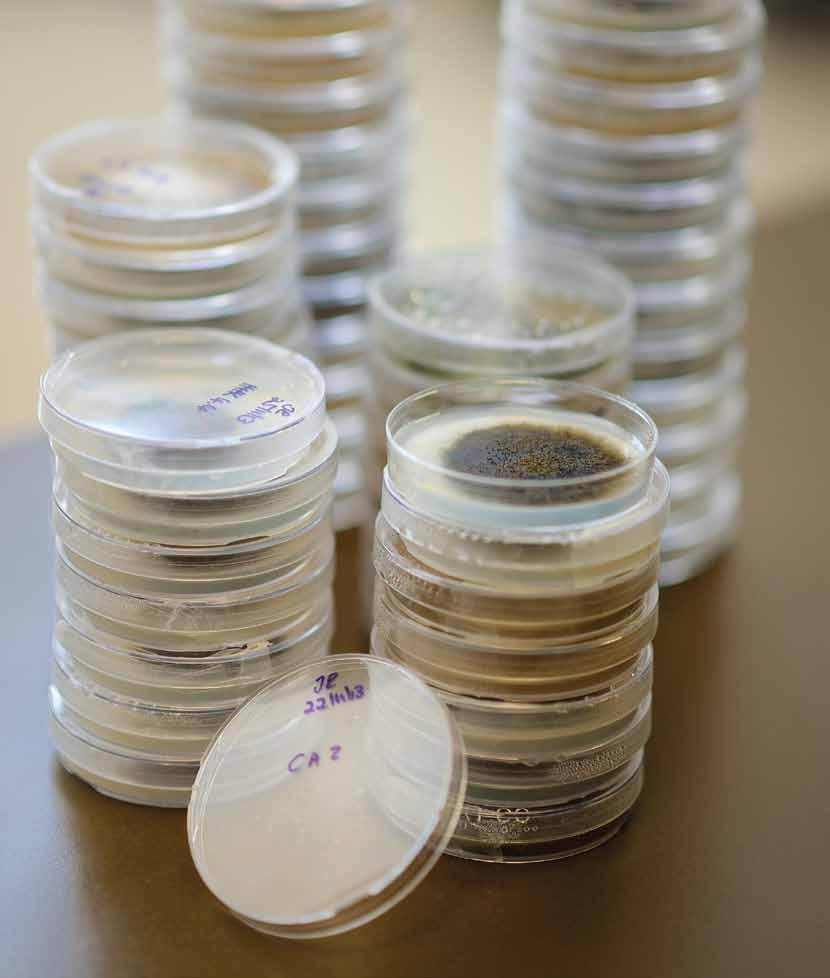

Difoka tša Thuto tša UP








The University of Pretoria congratulates the Exceptional Academic Achievers, the Teaching Excellence and Innovation Laureates and the 2013/2014 NRF-rated researchers on their achievements.
![]()
Difoka tša Thuto tša UP








The University of Pretoria congratulates the Exceptional Academic Achievers, the Teaching Excellence and Innovation Laureates and the 2013/2014 NRF-rated researchers on their achievements.

Verwelkoming
Exceptional Academic Achievers
Uitnemende Akademiese Presteerders
Bašomedi bao ba Atlegilego Kudu: Diakatemiki Prof
Prof
Prof
Prof
Prof
Prof
Prof
Exceptional Young Researchers
Uitnemende Jong Navorsers
Banyakišiši ba baswa bao ba Atleilego kudu Prof
Teaching Excellence and Innovation
Laureate Awards
Laureaattoekennings vir Uitnemendheid in Onderrig en Innovasie
Difoka tša Laureate tša Bokgoni bja go
Ruta le Botšo
NRF-rated Researchers 2013/2014
NNS-gegradeerde Navorsers 2013/2014
Banyakišiši bao ba abetšwego maemo ke NRF 2013/2014
A rated researchers A-gegradeerde navorsers
Banyakišiši ba tekanyo ya A
Banyakišiši ba ditekanyo tša B, C le Y

Prof Cheryl de la Rey
Vice-Chancellor and Principal, University of Pretoria
Visekanselier en Rektor, Universiteit van Pretoria
Motlatšamokhanseliri le Hlogo, Yunibesithi ya Pretoria
Through the annual UP Academic Achievers Awards, we pay tribute to the sustained efforts of our academic staff, who are individually and collectively driving the University’s strategy to be a leading research-intensive university in Africa, recognised internationally for our quality, relevance and impact. Balancing teaching and research as well as ensuring that our activities have a strong positive impact on our local communities requires dedication, diligence and passion. The 2014 suite of awards accords well-deserved recognition for exceptional achievement in the various aspects of academic life.
The Exceptional Achievers Award is based on outstanding achievement in research, teaching and learning and community engagement. Achievement in research is the basis of the Exceptional Young Researchers Award and research performance is also the central criterion of the National Research Foundation’s (NRF) rating system which is acknowledged by the University as a mechanism for benchmarking research performance at both national and international levels. Thus each year we pay tribute to academics who have been rated for the first time and those who have been successfully re-rated. This year we have also incorporated the Teaching and Learning Laureate Awards into the Academic Achievers Awards to ensure that we give due recognition to innovation in teaching and learning.
On behalf of the University community, I wish to congratulate all our Academic Achievers and express sincere appreciation for your valuable contribution to ensuring that the University of Pretoria grows from strength to strength in making a difference locally and globally.
UP se jaarlikse Toekennings vir Akademiese Presteerders huldig die volgehoue pogings van ons akademiese personeel wat individueel en gesamentlik die dryfkrag vorm vir die Universiteit se strategie om ’n toonaangewende navorsingsintensiewe universiteit in Afrika te wees en om internasionaal erkenning te geniet vir ons kwaliteit, toepaslikheid en impak. Dit verg toewyding en passie om ’n balans tussen onderrig en navorsing te behou en terselfdertyd te verseker dat ons aktiwiteite ’n sterk positiewe impak op ons plaaslike gemeenskappe het. Met die 2014-toekennings gee ons welverdiende erkenning vir uitsonderlike prestasie in die onderskeie aspekte van die akademie.
Die Toekenning vir Uitnemende Akademiese Prestasie word op grond van uitsonderlike prestasie in navorsing, onderrig en gemeenskapsbetrokkenheid gemaak. Prestasie in navorsing is die grondslag vir die Toekenning vir Uitnemende Jong Navorsers en is ook die sentrale kriterium vir die Nasionale Navorsingstigting (NNS) se graderingstelsel wat deur die Universiteit erken word as ’n meganisme vir die normering van navorsingsprestasie op sowel nasionale as internasionale vlak. Hiermee betoon ons elke jaar hulde aan akademici wat vir die eerste keer gegradeer is, asook aan dié wat weer eens gegradeer is. Vanjaar het ons die Laureaattoekennings vir Onderrig en Leer by die Toekennings vir Akademiese Presteerders ingesluit om te verseker dat ons ook die nodige erkenning aan innovasie in onderrig en leer gee.
Namens die Universiteitsgemeenskap wens ek al ons Akademiese Presteerders geluk en betuig ek opregte waardering vir die kosbare bydrae wat u lewer om te verseker dat die Universiteit van Pretoria plaaslik en wêreldwyd ’n al groter verskil maak.
Ka Difoka tša Bakgoni Dithutong tša ngwaga le ngwaga tša UP, re hlompha maitapišo ao a tšwelago pele a badirišane ba rena ba thuto, bao ka botee le ka kopanelo ba tšwetšago pele leano la Yunibesithi go ba yunibesithi ya ketapele ka nyakišišo ye e tseneletšego mo Afrika, re lemogwa ditšhabatšhabeng ka baka la boleng bja rena, bohlokwa le khuetšo. Go lekanetša go ruta le nyakišišo gammogo le go netefatša gore mešongwana ya rena e na le khuetšo ya go tia go ditšhaba tša rena tša gae e nyaka boikgafo, tlhokomelo le phišego. Sehlopha sa difoka tša 2014 di fa temogo ye e swanetšego ye botse go bokgoni bja go fetiša ka makaleng ao a fapanego a bophelo bja thuto.
Difoka tša Bakgoni ba go Fetiša di theilwe go bokgoni bja gabotse kudu ka nyakišišo, go ruta le go ithuta le kgafelo setšhabeng. Bokgoni nyakišišong ke motheo wa Difoka tša go Fetiša tša Banyakišiši ba ba Nnyane le phethagatšo ya nyakišišo gape ke mokgwa wa gare wa Motheo wa Nyakišišo wa Setšhaba (National Research Foundation’s (NRF) wa mokgwa wa go lekanetša woo o amogelwago ke Yunibesithi bjalo ka sedirišwa sa go ela phethagatšo ya nyakišišo mo magatong a setšhaba le ya ditšhabatšhaba. Ka moo ngwaga wo mongwe le wo mongwe re hlompha baakademiki bao ba lekanyeditšwego la mathomo le bao ba lekaneditšwego gape. Ngwaga wo re akareditše Difoka tša Laureate tša go Ruta le go Ithuta mo Difokeng tša Bakgoni Dithutong go netefatša gore re fa temogo ya maleba mo botšong bja go ruta le go ithuta.
Legatong la setšhaba sa Yunibesithi, Ke rata go lebogiša Bakgoni Dithutong gomme ke tšweletše ditebogo tša nnete ka tema ye le e kgathilego ya mohola go netefatša gore Yunibesithi ya Pretoria e a gola go tloga go maatla go ya maatla ka go dira phapano mo gae le lefaseng ka bophara.
This award is made annually to senior academics who have already achieved the status of professor, are regarded highly by their peers and have consistently excelled in the areas of under- and postgraduate teaching and learning, research, community service and administration over a period of time. Any academic who has been awarded an A-rating by the NRF in the year under consideration automatically qualifies as an Exceptional Achiever for as long as he or she remains an A-rated researcher.
Dié toekenning word jaarliks aan senior akademici gemaak wat reeds professorale status verwerf het, besonder hoë statuur onder hulle eweknieë geniet en oor ‘n geruime tydperk volgehoue uitnemende prestasies op die gebied van voor-en nagraadse onderrig en leer, navorsing, gemeenskapsdiens en administrasie behaal het. Enige akademikus wat deur die NNS as ‘n A-gegradeerde navorser geëvalueer is. in die jaar onder oorweging, word outomaties ‘n Uitnemende Presteerder vir so lank as wat hy of sy die status van ‘n A-gegradeerde navorser behou.
Bašomedi bao ba Atlegilego Kudu: Diakademiki Sefoka se se abelwa bafahloši bao ba lego maemong a godimo a seakatemiki ebile ba šetše ba fihleletše maemo a boprofesa gomme ba hlompšha ke ba mephato ya bona gape ba tšwelapele go šoma ka bothakga ka magorong a go ruta le go ithuta go baithuti ba maphoskratšuweiti le go bao e sego maphoskratšuweiti, dinyakišišong, tirelong ya setšhaba le tshepedišong godimo ga nako ya go bonala. Mofahloši o mongwe le o mongwe yo a fihleletšego maemo a NRF a (A) o kgotsofatša dinyakwa tša go tsenela legoro la Moatlegi wa go Tšwelela ka Magetla ka dinako ka moka ge a ntše a le monyakišiši wa maemo a (A).

Prof Roumen Anguelov
Prof Anguelov is head of the Department of Mathematics and Applied Mathematics in the Faculty of Natural and Agricultural Sciences.
His primary field of research is differential equations and their numerical analysis with the main emphasis on reliable numerical computations. His research in related areas, including spaces of interval-valued functions, type-independent theory of partial differential equations (PDEs) and image analysis, has also received recognition. In particular, his research on the space of Hausdorff continuous functions has shown that spaces of interval functions can play an important role in real analysis and in the analysis of PDEs. While his research results are important in their areas of application since they solve open problems or improve on earlier results, they also provide a significant new direction for development of interval analysis itself, namely the analysis of interval functions as part of real analysis against the prevailing current perception that interval analysis is no more than a tool for validated numerical computations.
In recent years Prof Anguelov’s work has been motivated to a large extent by applications of mathematics to the study of biological processes, as well as the development of mathematics inspired by biological applications. He plays a key role in promoting interdisciplinary collaboration in the general field of biomathematics at the University and is instrumental in the organisation of activities such as the BIOMATH Forum lecture series at the University and the International BIOMATH Conference.
He has served as guest editor of several special issues of reputable journals and is co-founder and editor-in-chief of the journal BIOMATH.
Prof Anguelov is hoof van die Departement Wiskunde en Toegepaste Wiskunde in die Fakulteit Natuur- en Landbouwetenskappe.
Sy belangrikste navorsingsgebied is differensiaalvergelykings en hul numeriese analise, met die hoofklem op betroubare numeriese berekenings. Hy geniet ook erkenning vir sy navorsing op verwante gebiede, wat spasies van intervalgeëvalueerde funksies, tipe-onafhanklike teorie van gedeeltelike differensiaalvergelykings (PDEs) en beeldanalise insluit. Dit is veral sy navorsing oor die spasie van Hausdorff se deurlopende funksies wat getoon het dat die spasies van intervalfunksies ’n belangrike rol kan speel in werklike analise en in die analise van PDEs. Sy navorsingsresultate is nie net belangrik omdat hulle op die gebied waarin hulle toegepas word bestaande probleme oplos of vroeëre resultate verbeter nie, maar ook omdat hulle ’n beduidende nuwe rigting vir die ontwikkeling van intervalanalise as sodanig bied, te wete die analise van intervalfunksies as deel van werklike analise, in teenstelling met die huidige algemene persepsie dat intervalanalise bloot ’n werktuig vir bevestigde numeriese berekenings is.
Gedurende die afgelope aantal jare is prof Anguelov se werk in groot mate gemotiveer deur die toepassings van wiskunde op die studie van biologiese prosesse, asook deur die ontwikkeling van wiskunde wat deur biologiese toepassings geïnspireer is. Hy speel ’n sleutelrol in die bevordering van interdissiplinêre samewerking op die algemene gebied van biowiskunde by die Universiteit en help met die reël van aktiwiteite soos die BIOMATH Forum-lesingreeks wat by die Universiteit aangebied word en die Internasionale BIOMATH-konferensie.
Hy het al as gasredakteur van verskeie spesiale uitgawes van hoog aangeskrewe vaktydskrifte gedien en is ’n medestigter en hoofredakteur van die tydskrif BIOMATH.
Prof Anguelov ke profesa le hlogo ya Kgoro ya Mmetse le Mmetse wa Tirišo ka Lefapheng la Disaense tša Tlhago le Temo.
Karolo ya nyakišišo ya gagwe ya motheo ke ditekano tša go fapana le phetleko ya senomoro go gatelela dipalelo tša senomoro tša go tshepagala. Nyakišišo ya gagwe dikgobeng tše di amanago, go akaretšwa dibaka tša mehola ya dikgala tša bohlokwa, mohuta wa teori wa go ikema wa ditekano tša go fapana tša go se felele le phetleko ya seswantšho, le wona o lemogilwe. E šupile, nyakišišo ya gagwe ya sekgoba sa mehola ya go tšwela pele ya Hausdorff e bontšhitše gore dikgoba tša mehola ya dikgala di ka raloka karolo ye bohlokwa ka phetleko ya kgonthe le ka phetleko ya ditekano tša go fapana tša go se felele. Le ge dipoelo tša nyakišišo ya gagwe di le bohlokwa mo dikgobeng tša tirišo ka ge di rarolla mathata ao a bonagalago goba e kaonafatša dipoelo tša ka pela, di fa gape taetšo ye mpsha ye bohlokwa ya tšweletšopele ya phetleko ya sekgala ka bo yona, e lego phetleko ya mehola ya sekgala e sego go feta sedirišwa sa dipalelo tša senomoro tšeo di hlatsetšwego.
Mengwageng ya bjale mešomo ya Prof Anguelov e hlohleleditšwe kudu ke ditirišo tša mmetse mo thutong ya ditshepedišo tša payolotši, gammogo le tšweletšopele ya mmetse wo fago mafolofolo ke ditirišo tša payolotši. O kgatha tema ye bohlokwa ka go tšwetša pele tirišano dikarolong tša go fapana tša mahlakore ka kakaretšo payommetse mo Yunibesithi gomme ke tša sedirišwa mo mokgatlong wa mešongwana ya go swana le ditatelano tša thutaphahlošo ya Foramo ya BIOMATH mo Yunibesithi le Khonferense ya BIOMATH ya Ditšhabatšhaba.
O thušitše bjalo ka morulaganyi wa moeng wa ditlhagišo tše mmalwa tša go ikgetha tša ditšenale gomme ke motheimmogo le morulaganyimmogolo wa tšenale ya BIOMATH.

Prof Marthán Bester
Prof Bester is professor in the Department of Zoology and Entomology in the Faculty of Natural and Agricultural Sciences and is affiliated to the Mammal Research Institute.
The main drive of his research in the South African National Antarctic Programme (SANAP) is the study of the population biology and population ecology of marine mammals in the Southern Ocean. The current monitoring programme of seals at the South African Prince Edward Islands (1983–2015) was his brain child. Current research includes satellite tracking of both elephant seals and fur seals and the determination of population dynamics of southern elephant seals. This serves conservation and management, as embodied in international conventions and the Prince Edward Islands Management Plan, and contributed substantially to the delineation of the surrounding marine protected area (MPA) in 2013.
Apart from papers delivered at national and international symposia and workshops, Prof Bester published 30 authored and co-authored peer reviewed articles in scientific journals and four book chapters in the last three years. Since 2011 five MSc students and two PhD students graduated under his supervision or co-supervision, with three of the master’s students graduating cum laude. He supervised four post-doctoral fellows and currently supervises three five-year research fellows at UP. Prof Bester (Pr. Sci. Nat) serves as a member of the ad hoc Committee on International Relations of the Society for Marine Mammalogy (SMM), the Tristan da Cunha Biodiversity Advisory Group (TBAG) and the Scientific Committee for Antarctic Research (SCAR) Action Group on Antarctic Fuel Spills (AGAFS). Since 2013 he has been a review editor for the Marine Ecology Progress Series (MEPS) and serves on the editorial boards of The Scientific World Journal and Polar Biology Nationally he is an associate editor of the South African Journal of Wildlife Research. He was recently invited by the Alfred Wegener Institute for Polar and Marine Research to participate in a research cruise to the Weddell Sea, Antarctica. Prof Bester is a B3 rated researcher with the NRF.
Prof Bester is professor in die Departement Dierkunde en Entomologie in die Fakulteit Natuur- en Landbouwetenskappe en is by die Soogdiernavorsingsinstituut geaffilieer.
Sy navorsing in die Suid-Afrikaanse Nasionale Antarktiese Program (SANAP) fokus op die studie van die bevolkingsbiologie en -ekologie van mariene soogdiere in die Suidelike Oseaan. Die huidige moniteringsprogram van robbe by die Suid-Afrikaanse Prins Edward-eilande (1983–2015) was sy idee. Huidige navorsing sluit in satellietopsporing van see-olifante en pelsrobbe en die bepaling van die bevolkingsdinamika van suidelike see-olifante. Dié navorsing bevorder bewaring en bestuur ooreenkomstig internasionale konvensies en die Bestuursplan vir die Prins Edward-eilande en het in ʼn groot mate bygedra tot die afbakening van die omringende beskermde seegebied in 2013.
Afgesien van referate by nasionale en internasionale simposiums en werkwinkels, was prof Bester oor die afgelope drie jaar outeur of mede-outeur van 30 portuurbeoordeelde artikels in wetenskaplike tydskrifte en vier hoofstukke in boeke. Sedert 2011 het hy as studieleier of medestudieleier vir vyf MSc- en twee PhD-studente opgetree. Drie van die meesterstudente het hul grade met lof verwerf. Hy hou tans toesig oor drie vyfjaar-navorsingsgenote by UP. Prof Bester (Pr. Sci. Nat) dien as lid van die internasionale Society for Marine Mammalogy (SMM) se ad hoc Komitee oor Internasionale Betrekkinge, die Tristan da Cunha Biodiversity Advisory Group (TBAG) en die Scientific Committee for Antarctic Research (SCAR) se Action Group on Antarctic Fuel Spills (AGAFS). Hy is sedert 2013 resensieredakteur vir die Marine Ecology Progress Series (MEPS) en dien op die redaksionele rade van The Scientific World Journal en Polar Biology. Plaaslik is hy mederedakteur van die South African Journal of Wildlife Research. Hy is onlangs deur die Alfred Wegener Institute for Polar and Marine Research genooi om aan ʼn navorsingsvaart na die Weddell-see in Antarktika deel te neem. Prof Bester het ’n B3-gradering van die NNS ontvang.
Prof Bester wa Kgorong ya Zoolotši le Enthimolotši ka Lefapheng la Disaense tša Tlhago le Temo gomme o tswalane le Institute ya Dinyakišišo ya Diamuši.
Nyakišišo ya gagwe ka Lenaneong la Naga la Afrika Borwa la Antarctic (South African National Antarctic Programme (SANAP)) e nepiša thuto ya batho ya payolotši le ya batho ya ekholotši ya diamuši tša lewatle, Lewatleng la Borwa (Southern Ocean). Lenaneo la bjale la tekolo la ditswalelo mo Dihlakahlakeng tša Afrika Borwa tša Morwakgoši Edward (South African Prince Edward Islands (1983 go fihla ka 2015) e be e le kgopolo ya gagwe. Nyakišišo ya bjale e akaretša latišišo ka sathalaete ya ditlou le ditswalelo tša boya le go laetša maatla a batho a tswalelo ya ditlou tša borwa. Se se thuša pabalelong le taolong, bjalo ka ge e akareditšwe ka go kgwerano ya ditšhabatšhaba le Thulaganyo ya Taolo la Dihlakahlaka tša Morwakgoši Edward (Prince Edward Islands Management Plan), gomme u e kgathile tema ye kgolo hlalošong ya lefelo le le šireleditšwego la go dikologa lewatle ka 2013.
Ka ntle ga dipampiri tše a di abilego disimphosiamong le mašomelo a mo gae le a ditšhabatšhaba, Prof Bester o phatlaladitše ka ditšenaleng tša saense diathekele tše a di ngwadilego goba tše a di ngwadilego mmogo tšeo di lekotšwego ke badirišane tše 30 le dikgaolo tša dipuku tše nne mo mengwageng ye meraro ya go feta. Go tloga ka 2011 baithuti ba ba hlano ba MSc le ba ba bedi ba PhD ba alogile ka fase ga tekolo le tekolommogo ya gagwe. O lekotše badirišane ba ka morago ga bongaka ba bane gomme ga bjale o lekola badirišane ba mengwaga ye mehlano ba UP. Prof Bester (Pr. Sci. Nat) o thuša leloko la Komiti ya Dikamano tša Ditšhabatšhaba tša Lekgotla la Diamuši tša Lewatle leo e sego la semmušo (ad hoc Committee on International Relations of the Society for Marine Mammalogy (SMM) Sehlopha sa Baeletši sa Tristan da Cunha sa Diphedi tše di Fapanego (Tristan da Cunha Biodiversity Advisory Group (TBAG) le Komiti ya Saense ya Nyakišišo ya Antarctic (SCAR)) Sehlopha sa Ditiro tša go Tšweletša Dibešwa (Action Group on Antarctic Fuel Spills (AGAFS). Go tloga ka 2013 o be a thuša bjalo ka morulaganyi wa go lekola wa Marine Ecology Progress Series (MEPS) gomme bjalo ka leloko la lekgotla la barulaganyi la Polar Biology. Mo gae ke mothuša morulaganyi wa South African Journal of Wildlife Research. Kgauswinyane o laleditšwe go tšwa go Institute ya Alfred Wegener ya Nyakišišo ya Phoula le Lewatle (Alfred Wegener Institute for Polar and Marine Research) ya go tšea karolo go leoto la nyakišišo la Lewatleng la Weddel, Antarctica Prof Bester o lekanyeditšwe ka nyakišišo ya B3 ke NRF.

Prof André Boraine
Prof Boraine is dean of the Faculty of Law. His name appears on the roll of practising attorneys and he is an honorary member of the South African Rescue and Insolvency Practitioners Association. He is a member of the Academics Forum of the International Association of Restructuring, Insolvency & Bankruptcy Professionals (INSOL) and also serves on its Global Fellowship Programme Committee.
Over the years he has taught a variety of law subjects at both undergraduate and postgraduate level. He is involved in practical legal training of candidate attorneys and insolvency practitioners. He was the INSOL Scholar for 2008–2009. His current research interests include insolvency law, the law of civil procedure, aspects of property law and consumer law. He has published widely and is a co-author of the leading South African textbook on insolvency, Insolvency law. He regularly presents papers at local and international conferences and holds a B1 rating from the NRF.
Prof Boraine is die dekaan van die Fakulteit Regsgeleerheid. Sy naam verskyn op die rol van praktiserende prokureurs en hy is ʼn erelid van die Suid-Afrikaanse Vereniging vir Reddings- en Insolvensiepraktisyns (South African Rescue and Insolvency Practitioners Association). Hy is lid van die forum vir akademici van die International Association of Restructuring, Insolvency & Bankruptcy Professionals (INSOL) en dien ook op dié liggaam se Global Fellowship Programme Committee.
Oor die jare heen het hy ʼn verskeidenheid regsvakke op sowel voor- as nagraadse vlak gedoseer. Hy is ook betrokke by die praktiese regsopleiding van kandidaatprokureurs en insolvensiepraktisyns en is as die 2008–2009 INSOL Scholar aangewys. Sy huidige navorsingsbelangstellings sluit insolvensiereg, siviele prosesreg, aspekte van eiendomsreg en verbruikersreg in. Prof Boraine het wyd gepubliseer en is medeouteur van die toonaangewende Suid-Afrikaanse handboek oor insolvensie, getitel Insolvency law. Hy lewer gereeld referate by plaaslike en internasionale konferensies en het in 2013 ’n B1-gradering van die NNS ontvang.
Prof Boraine ke Hlogo ya Lefapha la Molao. O mo mošomong wa boramolao gomme ke leloko la hlompho la Mokgatlo wa Ditsebi tša Tlhakodišo le go Tšhona wa Afrika Borwa. Ke leloko la Foramo ya Diakademiki ya Mokgatlo wa Ditšhabatšhaba wa Mpshafatšo ya go Tšhona, le Diithutedi tša Phedišo gomme o thuša gape Komiting ya yona ya Mananeo a Tirišano ya Lefase.
Mo mengwageng o rutile dithuto tša molao legatong la boithutelatikrii ya mathomo le la boalogabogolwane. O amana gape le tlhahlo ya molao ya tirišo ya balekwa ba boramolao le ditsebi tša go tšhona. E be e le Moithuti wa Mokgatlo wa Ditšhabatšhaba wa Mpshafatšo ya go Tšhona, le Diithutedi tša Phedišo go tloga ka 2008 go fihla ka 2009. Nyakišišo ya gagwe ya bjale e akaretša molao wa go tšhona, molao wa tshepedišo ya segae, mahlakore a molao wa dithoto le molao wa bareki. O phatlaladitše ka bophara gomme ke mongwadimmogo wa puku ya kgakollo ya ketapele ya Afrika Borwa ka ga go tšhona, Insolvency law. Nako le nako o tšweletša dipampiri dikhonferentsheng tša gae le tša ditšhabatšhaba gomme o na le tekanyo ya BI go tšwa go NRF.





Prof Riana Bornman
Prof Bornman is chief medical officer and extraordinary professor in the Department of Urology in the Faculty of Health Sciences. She heads the Andrology Section (male reproductive health) at the Steve Biko Academic Hospital.
Her initial research focused on the exposure of humans and wildlife to environmental endocrine disrupting chemicals (EDCs) and associated reproductive health effects. She reported the first cases of intersex in sharptooth catfish and testicular alterations in eland – changes similar to those in humans with testicular dysgenesis syndrome and urogenital defects (DSD) in newborn boys after in utero exposure to DDT. Current studies address early spontaneous miscarriage and neurodevelopmental impacts on children born in sprayed areas.
In subsequent studies related to DDT, the ‘prime’ EDC, she found intersex and ovarian defects in Mozambican tilapia and a high prevalence of DSDs in newborn boys, especially of stay-at-home mothers living in DDT-sprayed houses, thereby raising international concern over the health effects of DDT. She contributed to studies on young, healthy men where DDT exposure was associated with impaired semen quality and sperm chromatin defects. She presented and published on EDCs and DSDs in humans and wildlife of South Africa as harbingers of disease in the other. Prof Bornman collaborated in the compilation of the World Health Organisation (WHO)/United Nations Environment Programme (UNEP) Health risk of DDT 2011. She served on various UNEP-WHO committees dealing with environmental EDC exposure and contributed to the report, State of the science of endocrine disrupting chemicals 2012. As guest speaker at the International Society of Environmental Epidemiology in August 2013 and at several meetings of the Strategic Approach to International Chemicals Management she presented research on EDCs from an African perspective. She represents the African region on the Global EDC Policy Task Force, a leading body in EDC research in the USA and the European Union.
Prof Bornman is die hoof- mediese beampte en ’n buitengewone professor in die Departement Urologie, Fakulteit Gesondheidswetenskappe. Sy is hoof van die Afdeling Andrologie (manlike voortplantingsgesondheid) by die Steve Biko Akademiese Hospitaal.
Haar aanvanklike navorsing was gerig op die blootstelling van mense en wildlewe aan endokrieneversteuringschemikalieë (EDC’s) en die uitwerking daarvan op voorplantingsgesondheid. Sy het die eerste gevalle van intergeslagtelikheid in skerptandbabers en testikulêre veranderinge in elande aangemeld, veranderinge soortgelyk aan dié in mans met testikulêre disgenese sindroom en urogenitale defekte (DSD’s) in pasgebore seuns na in utero-blootstelling aan DDT. Haar huidige navorsing fokus op vroeë spontane miskraam en neuro-ontwikkelingsimpakte op kinders wat in bespuite gebiede gebore word.
In latere studies oor DDT, die primêre EDC, het sy intergeslagtelikheid en ovulêre defekte in Mosambiekse tilapia gevind, asook ʼn hoë voorkoms van DSD’s in pasgebore seuns van veral moeders wat in huise bly wat met DDT bespuit is. Dié bevindinge het internasionaal kommer gewek oor die uitwerking van DDT op gesondheid. Sy het bygedra tot navorsing oor die voorkoms van gebrekkige semenkwaliteit en chromatiendefekte in sperm in gesonde jong mans na blootstelling aan DDT. Sy het aanbiedings gedoen oor EDC’s en DSD’s in mense en wildlewe in Suid-Afrika as die voorlopers van siekte in die ander groep en ook daaroor gepubliseer. Prof Bornman het meegewerk aan die Wêreldgesondheidsorganisasie (WHO)/Verenigde Nasies se Omgewingsprogram (UNEP) se Health risk of DDT 2011. Sy het in verskeie UNEP-WHO-komitees oor blootstelling aan EDC’s in die omgewing gedien en bygedra tot die verslag, State of the science of endocrine disrupting chemicals 2012 As gasspreker by die International Society of Environmental Epidemiology in Augustus 2013 en by verskeie vergaderings van die Strategic Approach to International Chemicals Management het sy navorsing oor EDC’s vanuit die Afrika-perspektief aangebied. Sy verteenwoordig die Afrika-streek in die Global EDC Policy Task Force, ʼn toongaangewende liggaam op die gebied van navorsing oor EDC’s in die VSA en die Europese Unie.
Prof Bornman ke mohlankedimogolo wa kalafo le Profesa ya bokgoni Kgorong ya Yurolotši ka Lefapheng la Disaense tša Maphelo. Ke Hlogo ya Antrolotši (maphelo a tswala ya banna) mo Sepetleleng sa Akademi sa Steve Biko.
Nyakišišo ya gagwe ya mathomo e nepišitše ponagalo ya khemikhale yeo e amago endokrini ya tikologo le dio tša maphelo tšeo di amanago le tswalo mo bathong le diphoofolong. O begile tiragalo ya mathomo ya tsenelano ya bong mo go catfish ya meno a matelele le diphetogo tšatheskhula tša diphetogo tša eland tšeo di swango le tša motho tša ditho tša bolwetši bja taetšonesisi le mafokodi a a yurotšenithale kamano ya DSD mo bašemaneng bao ba sa tšwago go belegwa le ponagalo ya popelo ya DDT. Nyakišišo ya bjale e bolela ka go goma tseleng ga tlhago le go se gole gabotse ga dinyurone baneng bao ba dulago mafelong ao a gašitšwego.
Mo dithutong tša gagwe tša go latela tše di amanago le DDT, ‘prime’ EDC o hweditše tsenelano ya mafokodi popelong ka tilapia ya Mozambique le tšwelelo ya godimo ya di DSD mo bašemaneng bao ba sa tšwago go belegwa ya bomma bao ba dulago ka gae ka dintlong tšeo di gašitšwego tša DDT ka moo tša tsoša letšhogo la ditšhabatšhaba. O kgathile tema thutong ya banna ba ba nnyane bao ba phetšego gabotse moo ponagalo ya DDT e amanywago le khwalithi ya semene le go palelwa ga kromatini ya sepemo.
Prof Bornman o šomišane le Mokgatlo wa Maphelo wa Lefase/Lenaneo la Tikologo la Ditšhabakopano kotsi ya Maphelo ya DDT 2011 (World Health Organisation (WHO)/United Nations Environment Programme (UNEP) Health risk of DDT 2011). O thušitše dikomiting tša go fapana tša UNEP-WHO a šoma ka ponagalo ya tikologo ya EDC gomme a kgathaa tema go State of the science of endocrine disrupting chemicals ka 2012. Bjalo ka seboledi sa moeng mo Lekgotleng la Ditšhabatšhaba la Ephitimolotši ka Phato 2013 le mehlakanong ye mentši ya Mekgwa ya Peakanyo ya Ditšhabatšhaba ya Taolo ya Dikhemikhale (Approach to International Chemicals Management ) o abile nyakišišo ka di EDC ka ponagalo ya Afrika. O emela selete sa Afrika ka Global EDC Policy Task Force, mokgatlo wa ketapele ka nyakišišo ya EDC kua USA le Euopean Union.

Prof Erika de Wet
Prof De Wet is co-director of the Institute for International and Comparative Law in Africa and professor of International Law in the Faculty of Law. Between 2004 and 2012 she was professor of International Constitutional Law at the University of Amsterdam. She regularly lectures at the University of Bonn.
The areas of research in which she has gained international recognition include the law of international organisations with specific focus on the powers of the United Nations Security Council, the relationship between international law and domestic law, and issues pertaining to normative hierarchy in international law (international constitutionalism).
Prof De Wet recently received a B1 rating from the NRF (2010–2014), the Stellenbosch Institute for Advanced Study in South Africa Fellowship (September 2013) and the Vici Excellence Grant from the Netherlands Organisation for Scientific Research (2007–2012). In 2010 she was first runner-up in the Women in Science Awards of the South African Department of Science and Technology (category Social Sciences and Humanities).
Recent publications by Prof De Wet that received international recognition include the article ‘From Kadi to Nada: judicial techniques favouring human rights over United Nations Security Council sanctions’ (published in 2013 in the Chinese Journal of International Law, 12: 787–808), the book chapter ‘Jus cogens and obligations erga omnes’ (published in 2013 in Dinah Shelton (ed), The Oxford handbook on international human rights law, Oxford: Oxford University Press, 541–561) and Hierarchy in international law: the place of human rights, which she co-edited with Jure Vidmar, published by Oxford University Press in 2012.
Prof De Wet is ’n mededirekteur van die Instituut vir Internasionale en Vergelykende Reg in Afrika en professor in Internasionale Reg in die Fakulteit Regsgeleerdheid. Vanaf 2004 tot 2012 was sy professor in Internasionale Konstitusionele Reg aan die Universiteit van Amsterdam. Sy doseer ook gereeld aan die Universiteit van Bonn.
Navorsingsgebiede waarin sy internasionale erkenning geniet is onder andere internasionale organisasiereg, met ’n spesifieke fokus op die magte van die Veiligheidsraad van die Verenigde Nasies, die verhouding tussen internasionale en plaaslike reg, en aangeleenthede rondom die normatiewe hiërargie in internasionale reg (internasionale konstitusionalisme).
Prof De Wet het onlangs (2010–2014) ’n B1-gradering van die NNS ontvang, asook ʼn genootskap van die StellenboschInstituut vir Gevorderde Studie in Suid-Afrika (September 2013) en die Vici-beurs vir Uitnemendheid van die Nederlandse Organisasie vir Wetenskaplike Navorsing (2007–2012). In 2010 was sy die naaswenner in die Vroue in Wetenskaptoekennings van die Suid-Afrikaanse Departement van Wetenskap en Tegnologie (kategorie sosiale en geesteswetenskappe).
Onder die onlangse publikasies waarvoor prof De Wet internasionale erkenning ontvang het, is die artikel getitel ‘From Kadi to Nada: judicial techniques favouring human rights over United Nations Security Council sanctions’ (wat in 2013 in die Chinese Journal of International Law, 12: 787–808 verskyn het), die hoofstuk ‘Jus cogens and obligations erga omnes’ (in 2013 in Dinah Shelton (red) se The Oxford handbook on international human rights law, Oxford: Oxford University Press, 541–561) en Hierarchy in international law: the place of human rights, met Jure Vidmar as mederedakteur, wat in 2012 deur Oxford University Press uitgegee is.
Prof De Wet ke molaodimmogo wa Institute ya Molao wa Ditšhabatšhaba le wa Papetšo ka Afrika le profesa ya Molao wa Ditšhabatšhaba mo Lefapheng la Molao. Gare ga 2004 le 2012 e be e le profesa ya Molaotheo wa Ditšhabatšhaba Yunibesithing ya Amsterdam gomme o fahloša nako le nako Yunibesithing ya Bonn. Dikgoba tša nyakišišo tšeo a amogetšego temogo ya ditšhabatšhaba di akaretša molao wa mekgatlo ya ditšhabatšhaba ka nepišo ye e itšego mo go maatla a Khansele ya Tšhireletšo ya Ditšhabakopano, kamano gare ga molao wa ditšhabatšhaba le molao wa gae, le dilo tšeo di lebanego le tatelano ya kelo go molao wa ditšhabatšhaba (molaotheo wa semmušo wa ditšhabatšhaba).
Prof De Wet kgauswinyane o amogetše tekanyo ya B1 ya NRF (2010 go fihla ka 2014), Institute ya Dithuto tše di Phagameng ya Stellenbosch ya Tirišano ya Afrika Borwa (Lewedi 2013) le Thušo ya Bokgoni ya Vici go tšwa Mokgatlong wa Nyakišišo ya Mahlale ya Netherlands (2007 go fihla ka 2012). Ka 2010 e bile wa mathomo mo Difokeng tša Bokgoni tša Basadi ka Saenseng tša Kgoro ya Saense le Theknolotši ya Afrika Borwa (legoro la disaense tša leago le bomotho)
Diphatlalatšo tša kgauswinyane tša Prof De Wet tšeo di amogetšego temogo ya ditšhabatšhaba di akaretša athekeke ya ‘From Kadi to Nada’: dithekniki tša molao tšeo di tlhaolago ditokelo tša batho mo dikiletšong tša Khansele ya Tšhiriletšo ya Kopanoditšhaba (e phatlaladitšwe ka 2013 ka Chinese Journal of International Law, Vol 12, 787–808) kgaolo ya puku ‘Jus cogens and obligations erga omnes’ (e phatlaladitšwe ka 2013 mo kgatišong ya Dinah Shelton, The Oxford handbook on international human rights law, Oxford: Oxford University Press, 541–561) le Hierarchy in international law: the place of human rights, yeo a e rulagantšego mmogo le Jure Vidmar, gomme e phatlaladitšwe ke Oxford University Press ka 2012.

Prof Greeff is professor in the Department of Genetics in the Faculty of Natural and Agricultural Sciences.
His research focuses on the evolution of interactions between relatives and the evolution of reproductive strategies. Prof Greeff and his group of researchers have shown that fig wasp mothers carefully regulate the number of male offspring they produce to minimise competition among male offspring. If competition among fig wasp males is too intense they evolve robust morphologies and fighting behaviour. In future, the research group wants to explore the evolution of virulence because it is claimed to be analogous to sex ratios and sibling rivalry in that competition among parasites can result in higher virulence which can be mitigated by relatedness. The research group is currently quantifying the population structure and mating behaviour of parasites to understand the relatedness structure of parasitic populations.
Studying these population genetic structures and the mating systems of parasites links up with Prof Greeff’s interest in the evolution of mating strategies. Reproductive strategies are studied using theoretical models to predict optimal behaviour and by quantifying the effects of key parameters illustrated in models. His research also describes the mating strategies of unknown species and look at the fitness effects of various strategies. Recently his group considered the beneficial role of inbreeding and how it is balanced with inbreeding depression, as well as the evolution, causes and consequences of infertility in humans.
Another research project focuses on the genetic heritage of the Afrikaner population, taking stock of the racial admixture during the inception of the population and selection in the subsequent 350 years. This data has brought to light interesting linkages with reproductive strategies in humans. Prof Greeff received a NRF B2 rating in 2011.
Prof Greeff is professor in die Departement Genetika in die Fakulteit Natuur- en Landbouwetenskappe.
Sy navorsingsfokus is die evolusie van interaksies tussen lede van dieselfde familie en die evolusie van voortplantingstrategieë. Prof Greeff en sy navorsingsgroep het getoon dat vywespmoeders die aantal manlike nageslag wat hulle produseer noukeurig reguleer ten einde mededinging tussen manlike nasate te minimaliseer. Indien die mededinging tussen manlike vywespe te intens is, ontwikkel hulle kragtige morfologieë en gevegsgedrag. In die toekoms wil die navorsingsgroep die evolusie van virulensie ondersoek, aangesien dit na bewering analoog is aan geslagsverhoudings en mededinging tussen sibbe in die sin dat kompetisie tussen parasiete tot verhoogde virulensie aanleiding gee, wat deur nabye verwantskap getemper kan word. Die navorsingsgroep is tans besig om die bevolkingstruktuur en paringsgedrag van parasiete te kwantifiseer ten einde hul begrip van die verwantskapstruktuur van parasitiese bevolkings te verbeter.
Die bestudering van hierdie genetiese strukture van bevolkings en die paringstelsels van parasiete vind aansluiting by prof Greeff se belangstelling in die evolusie van voortplantingstrategieë. Dié strategieë word met behulp van teoretiese modelle bestudeer om optimale gedrag te voorspel en deur die uitwerkings van die sleutelparameters wat in die modelle geïllustreer word te kwantifiseer. Sy navorsing beskryf ook die paringstrategieë van onbekende spesies en kyk na die toepaslikheid van verskillende strategieë. Sy groep het onlangs oorweging geskenk aan die voordelige rol van inteling en hoe dit deur intelingsdepressie gebalanseer word, asook aan die evolusie, oorsake en gevolge van infertiliteit in die mens.
Nog ʼn navorsingsprojek fokus op die genetiese erfenis van die Afrikanerbevolking, met inagneming van die rassevermenging tydens die onstaan van die bevolking en seleksie gedurende die daaropvolgende 350 jaar. Hierdie gegewens het interessante skakelings met voortplantingstrategieë in die mens aan die lig gebring. Prof Greeff het in 2011 die NNS se B2-gradering ontvang.
Prof Greeff ke profesa ka Kgorong ya Leabela mo Lefapheng la Disaense tša Tlhago le Temo.
Nyakišišo ya gagwe e nepiša ebolušene ya tsenelelano gare ga meloko le ebolušene ya mekgwa ya tswalo. Prof Greeff le sehlopha sa gagwe sa banyakišiši ba bontšhitše gore lego la mantlakane la ditshadi le laola ka tlhoko palo ya bana ba tona leo le ba tšweletšago go fokotša phadišano go bana ba ba tona.
Ge phadišano gare ga bana ba ba tona e le ye maatla ba fetoša dimofolotši tše maatla le maitshwaro a go lwa. Nakong ye e tlago sehlopha sa nyakišišo se nyaka go utolla ebolušene ya baerulense ka gore gothwe di swana ka kabo ya bong le phadišano ya tswalano ka phadišanong ya dipharasaete e ka tšweletša baerulense ya godimo yeo e ka fokotšwago ke tswalano. Sehlopha sa nyakišišo ga bjale se bala sehlopha sa sebopego sa diphedi le a maitshwaro a dipharasaete a tswalo go kwešiša sebopego sa tswalano ya diphedi tša dipharasaete.
Go ithuta sebopego se sa leabela la diphedi tše le mekgwa ya tswalo ya dipharasaete go kgokaganya le kgahlego ya Prof Greeff mo ebolušeneng ya mekgwa ya tswalo. Mekgwa ya tswalo go e ithutwa go šomiša dikao tša teori go laola maitshwaro a mabotse go feta ka moka le go bala dilo diparameta tše bohlokwa tšeo di laeditšwego ka sekaong. Nyakišišo ya gagwe e hlaloša gape mekgwa ya tswalo ya diphedi tšeo di sa tsebjego gomme gwa lebelelwa le khuetšo ya bokgoni bja mekgwa ya go fapana. Kgauswinyane sehlopha sa gagwe se lebeletše tema ya mohola ya tswadišo ka leloko le ka moo e lekanetšwago le hlonamo ya tswadišo ka leloko, gammogo le ebolušene, seo se hlolago le dipoelo tša go se belege ga batho.
Protšeke ye nngwe ya nyakišišo e nepiša bohwa bja leabela ya batho ba Maafrikanere, go bala tswalano ya go hlakana ga merafe nakong ya go thoma ga batho le kgetho mo mengwageng ye e latelago ye 350. Data ye e tšweleditše dikgokanyi tša go kgahliša le mekgwa ya pelego ya batho. Prof Greef o amogetše tekanyo ya B2 ya NRF ka 2011.

Prof Joubert is professor in the Department of Electrical, Electronic and Computer Engineering in the Faculty of Engineering, Built Environment and Information Technology, where he heads the Electromagnetism Research Group.
Prof Joubert does research on microwave antennas, inter alia on the size reduction of antennas as a result of communication devices becoming smaller owing to the integration of electronics. The miniaturisation of an antenna has a significant impact on its performance, and designing small antennas of satisfactory performance in terms of power handling, radiation pattern and bandwidth has become a very challenging undertaking.
As integration increases, a single antenna is often used to support two or more wireless services across a broad frequency range, in which case an antenna with multi-band or wideband characteristics is required. Metamaterials are artificial materials specifically engineered to provide properties that may not be readily available in nature. The concept of a novel reactive impedance surface (RIS) as substrate for planar antennas (specifically dipole and patch antennas), which can miniaturise size and significantly enhance both bandwidth and radiation characteristics of an antenna has been demonstrated. Antenna arrays and the development of new approaches for using such arrays to improve system performance are continually being investigated. Antenna arrays can be used in conjunction with signal processing techniques such as spatial and space-time adaptive processing to optimise the received signal.
The Electromagnetism Research Group uses the compact test range to research the characterisation of antennas through measurement and the improvement of antenna measurement techniques. From July to September 2010, Prof Joubert was visiting scientist at Loughborough University in the United Kingdom, where he collaborated on a research project on the enhancement of slot radiators through the use of metamaterials.
Prof Joubert is ’n professor in die Departement Elektriese, Elektroniese en Rekenaar-Ingenieurswese in die Fakulteit Ingenieurswese, Bou-omgewing en Inligtingstegnologie, waar hy aan die hoof van die Elektromagnetismenavorsingsgroep staan.
Prof Joubert doen navorsing oor mikrogolfantennes, onder meer oor die vermindering in die grootte van antennes namate kommunikasietoestelle as gevolg van die integrasie van elektronika al kleiner word. Die miniaturisasie van ʼn antenne het ʼn beduidende impak op die werkverrigting daarvan. Die ontwerp van klein antennes met bevredigende werkverrigting ten opsigte van kraghantering, stralingspatroon en bandbreedte is ʼn baie groot uitdaging.
Namate integrasie toeneem, word ʼn enkele antenne dikwels gebruik om twee of meer radiodienste oor ʼn breë reikwydte te ondersteun, in welke geval ʼn antenne met multi- of breëbandeienskappe vereis word. Metamateriale is kunsmatige materiale wat spesifiek ontwerp is om eienskappe wat nie geredelik in die natuur beskikbaar is nie te besit. Die konsep van ʼn nuwe reaktiewe impedansieoppervlak (RIS) as substraat vir planêre antennes (spesifiek dipool- en plakantennes) wat grootte kan miniaturiseer en sowel die bandbreedte as die stralingkenmerke van ʼn antenne beduidend kan verbeter, is gedemonstreer. Antennesamestellings en die ontwikkeling van nuwe benaderings in die gebruik daarvan om stelselwerkverrigting te verbeter, word voortdurend ondersoek. Antennesamestellings kan tesame met seinprosesseringstegnieke soos ruimtelike en ruimte-tyd aanpasbare-verwerking gebruik word om die ontvangssein te verbeter.
Die Elektromagnetisme-navorsingsgroep gebruik die kompakte toetsbaan om die karakterisering van antennes deur meting en die verbetering van antennemetingstegnieke na te vors. Van Julie tot September 2010 was prof Joubert ’n besoekende wetenskaplike aan die Loughborough-universiteit in die Verenigde Koninkryk, waar hy meegewerk het aan ʼn navorsingsprojek oor die verbetering van gleufstralingselemente deur die benutting van metamateriale.
Prof Joubert ke profesa ka Kgorong ya Mohlagase, Elektroniki, Boentšenere bja Elekroniki le Khomputha ka Lefapheng la Boentšenere, Kago ya Tikologo le Theknolotši ya Tshedimošo, moo e lego hlogo ya Sehlopha sa Nyakišišo ya Maatlakgogedi a Mohlagase.
Prof Joubert o dira nyakišišo ka dinakana tša lephotonyana, gare ga tše dingwe ka go fokotša bogolo bja dinakana ka lebaka la didirišwa tša kgokagano di eba tše di nnyane ka lebaka la kopanyo ya dielektroniki. Go hunyela ga nakana go na le khuretšo ye kgolo mo phethagatšong ya yona, le go dira dinakana tše di nnyane tša phethagatšo yeo e kgotsofatšago go ya ka moo e swarago maatla ka gona, patrone ya kedišo le bophara bja lepanta e bile mošomo wa tlhohlo.
Ge kopanyo e gola, nakana e tee gantši e a šomišwa go thekga ditirelo tše pedi goba go feta tša seyalemoya go katologanyo ya boipoeletšo ka bophara, ka tsela yeo nakana ye e nago mapanta a go feta le tee goba pharologantšho ya lepanta la bophara le a nyakega. Dimetamateriale ke dimetameteriale tša maitirelo tšeo di diretšwego go fa seeng tšeo di sa hwetšagalego ka hlago. Kgopolo ya novel reactive impedance surface (RIS) bjalo ka dinakana tša planere (kudu dipole le radietara tša go khupetša), tšeo di ka fokotšago bogolo le go kaonafatša lepanta la bophara le dibopego tša kedišo ya dinakana e bontšhitšwe. Dihlopha tša dinakana le tšweletšopele ya mekgwa ye meswa ya go šomiša dihlopha tšeo go kaonafatša mokgwa wa phethagatšo e nyakišišwa go tšwelapele.
Dihlopha tša dinakana di ka šomišwa le dithekniki tša tshepetšo ya temoši go swana le lesetafase le sekgoba – tshepedišo ya kaonafatšo e amogetše leswao. Sehlopha sa Nyakišišo ya Elekromaknetisimi se šomiša mohlwaela wa teko ye e tiilego go nyakišiva dibopego tša dinakana ka kelo le kaonafatšo ya dithekniki tša kelo ya nakana. Go tloga ka Phupu go fihla ka Lewedi 2010, Prof Joubert e be e le rasaense wa moeng Yunibesithing ya Loughborough United Kingdom, moo a šomišanego le ba bangwe ka protšeke ya nyakišišo ka kaonafatšo ka diradietara ka go šomiša dimetamateriale.

Prof Lise Korsten
Prof Korsten is professor in the Department of Microbiology and Plant Pathology in the Faculty of Natural and Agricultural Sciences. She heads the thematic focus area of Food Safety, Biosecurity, Public Health and Regulatory Control within the Institute for Food, Nutrition and Well-being (IFNuW).
Prof Korsten developed South Africa’s first biological control agent for fruit and has established a research group in sanitary and phytosanitary aspects of international trade. She has expanded her research portfolio to include aspects related to postharvest pathology and food safety in the fresh produce supply chain. The fact that Prof Korsten serves on the boards of the National Laboratory Association (2005–2014), the Post-harvest Innovation (PHi) Programme of the Department of Science and Technology and of the Fresh Produce Exporters Forum (2009–2013) attests to her stature. She is a member of the Specialist Technical Committee of the South African National Accreditation System (SANAS) and has been a technical assessor for SANAS since 2001. She has received the University of Pretoria’s Exceptional Achiever Award three times and the SANAS Special Recognition Award twice, in recognition of her significant contribution to improving and promoting SANAS accreditation. She is a fellow of the South African Society for Plant Pathology, was elected by the International Society for Plant Pathology as chair of the Global Food Security Task Force and was also elected to serve on the Postharvest Subject Matter Committee.
Prof Korsten has supervised 12 PhD and 40 master’s students. She has published extensively, including 104 peer-reviewed papers and books or book chapters,19 full-length conference proceedings and 115 industry papers. She has registered two patents and presented 105 international papers of which 28 were key note addresses, and 248 national papers or posters, of which 34 were key note addresses. She has served as external examiner for eight master ’s and five doctoral degrees, evaluated numerous research proposals and grant applications and served on the NRF assessment panel for rated scientists. Prof Korsten received a B2 rating from the NRF.
Prof Korsten is professor in die Departement Mikrobiologie en Plantpatologie in die Fakulteit Natuur- en Landbouwetenskappe. Sy staan aan die hoof van die navorsingstema Voedselveiligheid, Biosekerheid, Openbare Gesondheid en Regulatoriese Beheer in die Instituut vir Voedsel, Voeding en Welstand (IFNuW).
Prof Korsten het Suid-Afrika se eerste biologiese beheeragent vir vrugte ontwikkel en het ʼn navorsingsgroep tot stand gebring wat sanitêre en fitosanitêre aspekte van die internasionale handel ondersoek. Sy het haar navorsingsportefeulje uitgebrei om aspekte verwant aan ná-oespatologie en voedselveiligheid in die varsproduktevoorsieningsketting in te sluit. Die feit dat prof Korsten op die rade van die Nasionale Laboratoriumvereniging (2005–2014), die Ná-oesinnoveringsprogram (PHi) van die Departement van Wetenskap en Tegnologie en die Forum van Varsprodukteuitvoerders (2009–2013) dien, dui op die aansien wat sy geniet. Sy is ’n lid van die Spesialis Tegniese Komitee van die Suid-Afrikaanse Nasionale Akkreditasiestelsel (SANAS) en is sedert 2001 ʼn tegniese assessor vir SANAS. Prof Korsten het verskeie spesiale toekennings ontvang, onder meer die Universiteit van Pretoria se toekenning vir uitnemende akademiese presteerder (drie keer) en spesiale erkenning deur SANAS vir haar waardevolle bydrae tot die verbetering en bevordering van SANAS-akkreditering (2011). Sy is ʼn genoot van die Suid-Afrikaanse Vereniging vir Plantpatologie, is deur die International Society for Plant Pathology tot voorsitter van die Global Food Security Task Force verkies en dien ook op die Postharvest Subject Matter Committee.
Prof Korsten het reeds as studieleier vir 12 PhD- en 40 meesterstudente opgetree. Haar uitgebreide lys publikasies sluit 104 portuurbeoordeelde artikels en boeke of hoofstukke in boeke, 19 vollengte-konferensieverrigtinge en 115 nywerheidsreferate in. Sy het ook twee patente geregistreer en 105 internasionale referate, waarvan 28 as hoofspreker was, en 248 nasionale referate, wat 34 as hoofspreker ingesluit het, gelewer. Sy was ’n eksterne eksaminator vir agt meesters- en vyf doktorsgrade, het talle navorsingsvoorstelle en beurskandidate geëvalueer en het op die NNS se assesseringspaneel vir gegradeerde wetenskaplikes gedien. Prof Korsten het ’n B2-gradering van die NNS ontvang.
Prof Korsten ke profesa ka Kgorong ya Maekropayolotši le Phatolotši ya Dimela ka Lefapheng la Disaense tša Tlhago le Temo. Ke hlogo ya sekgoba sa nepišo ya thematiki ya Polokego ya Dijo, Paeyosekhuriti, Maphelo a Setšhaba le Taolo ya Melao ka Instituting ya Dijo, Phepo le Go phela gabotse ga batho (Institute for Food, Nutrition and Well-being (IFNuW).
Prof Korsten o godišitše mmaditsela wa mathomo wa taolo ya hlago wa Afrika Borwa wa dienywa gomme o hlomile sehlopha sa nyakišišo ka mahlakore a papatšo ya ditšhabatšhaba ya tlhwekišo le tlhwekišo ya dimela. O katolišitše potfolio ya gagwe ya nyakišišo go akaretša mahlakore ao a phatolotši ya ka morago ga puno le polokego ya dijo lekaleng la go sepediša tšweletšo ye mpsha. Ntlha ya gore Prof Korsten o thušitše makgotleng a Mokgatlo wa Laporatori ya Setšhaba (2005 go fihla ka 2014), Lenaneo la Boithomelo la ka morago ga Puno la Kgoro ya Saense le Theknolotši le la Foramo ya Go Iša ntle Tšweletšo ye Mpsha (2009–2013) e kgonthiša maemo a gagwe. Ke leloko la Komiti ya Bomatwetwe ba Thekniki ya Lenaneo la Tumelelo la Setšhaba la Afrika Borwa (Specialist Technical Committee of the South African National Accreditation System (SANAS) gomme e bile moahlodiše wa thekniki ya SANAS go tloga ka 2001. O amogetše Sefoka sa ba go kgona kudu sa Yunibesithi ya Pretoria makga a mararo le Sefoka sa Temogo ya go Ikgetha sa Bomatwetwe ba Thekniki ya Lenaneo la Tumelelo la Setšhaba la Afrika Borwa (Specialist Technical Committee of the South African National Accreditation System (SANAS) gabedi, go lemogwa tema ye bohlokwa yeo a ikgathilego go kaonafatša le go tšwetša pele tumelelo ya SANAS. Ke modirišane wa Mokgatlo wa Phatolotši ya Dimela wa Afrika Borwa (South African Society for Plant Pathology), o kgethilwe bjalo ka modulasetulo wa Sehlophatšhomo sa Lefase sa Polokego ya Dijo ke Mokgatlo wa Lefase wa Phatolotši ya Dimela gape o kgethilwe go thuša Komiting ye e lebeletšeng Ditaba tša ka Morago ga Puno (Postharvest Subject Matter Committee).
Prof Korsten o lekotše baithuti ba PhD ba 12 le ba mastase ba 40. O phatlaladitše kudu, go akaretša le dipampiri le dipuku/ dikgaolo tša tšeo di lekotšwego ke badirišane (104), ditshepetšo tša khonferense ye e feletšego (19), o ngwadišitše ditokelo tša ngwalollo tše pedi, o phatlaleditše dipampiri tša intasteri tše 115, gomme o abile dipampiri tša ditšhabatšhaba tše 105 tšeo tše 28 tša tšona e bego e le dinotetheo gomme tše 248 e le dipampiri tša setšhaba goba diphoustara, tšeo 34 ya theo ya setšhaba e bego e le dipolelo tša notetheo. O thušitše bjalo ka mohlahlobibontle dimastase tše seswai le di PhD tše hlano, o lekotše ditšhišinyo tša nyakišišo le dithušo tša mašeleng a dithuto tše mmalwa gomme a thuša mo sehlopheng sa tekanyetšo sa NRF sa boramahlale ba ba lekanyeditšwego. Prof Korsten o amogetše tekanyo ya B2 go tšwa go NRF.

Prof Maree is professor in the Department of Educational Psychology in the Faculty of Education. His main research interest is career construction counselling and life designing and construction. He links research results to appropriate career choices and construction and to life designing and construction.
Former editor of the South African Journal of Psychology, managing editor of Gifted Education International, co-editor of the SA Journal of Science and Technology and a member of several national and international bodies, he has authored more than 120 peer reviewed articles and 60 books or chapters in books since the beginning of 2004. In 2009 he received the Stals Prize of the Suid-Afrikaanse Akademie vir Wetenskap en Kuns for exceptional research and contributions to psychology. He was awarded the Chancellor’s Medal for Teaching and Learning by the University of Pretoria in 2010. He received a B3 rating from the NRF.
Prof Maree’s most recent publications include: Counselling for career construction: connecting life themes to construct life portraits. Turning pain into hope. Rotterdam: Sense (2013); ‘Career-Adapt-Abilities Scale: South African form: psychometric properties and construct validity’, Journal of Vocational Behaviour, doi: 10.1016/j.jvb.2012.01.005 (2012); A guide to reflective career counselling. DVD. Randburg: Jopie van Rooyen & Partners (2012).
A regular keynote speaker, Prof Maree was invited to be a State-of-the-Sciences speaker at the International Congress of Applied Psychology, the flagship event on the international psychology calendar, which will be held from 8 to13 July 2014 in Paris. On this occasion he will speak on ‘Connecting life-themes to construct self-portraits’.
Prof Maree is professor in die Departement Opvoedkundige Sielkunde in die Fakulteit Opvoedkunde. Sy navorsing is veral toegespits op loopbaankonstruksievoorligting en lewensontwerp en konstruksie. Hy verbind navorsingsresultate met gepaste loopbaankeuses en -konstruksie, asook met lewensontwerp en konstruksie.
Hy is ʼn voormalige redakteur van die South African Journal of Psychology, besturende redakteur van Gifted Education International, mederedakteur van die SA Journal of Science and Technology en lid van verskeie vakverwante nasionale en internasionale liggame. Sedert die begin van 2004 het prof Maree reeds meer as 120 portuurbeoordeelde artikels en 60 boeke of hoofstukke in boeke geskryf. In 2009 het hy die Stals-prys van die Suid-Afrikaanse Akademie vir Wetenskap en Kuns ontvang vir voortreflike navorsing oor en bydraes tot die sielkunde. In 2010 het die Universiteit die Kanseliersmedalje vir Onderrig en Leer aan hom toegeken. Hy het ’n B3-gradering van die NNS ontvang.
Prof Maree se mees onlangse publikasies sluit in:
Counselling for career construction: connecting life themes to construct life portraits. Turning pain into hope. Rotterdam: Sense (2013); ‘Career-Adapt-Abilities Scale: South African form: psychometric properties and construct validity’, Journal of Vocational Behaviour (doi: 10.1016/j.jvb.2012.01.005) (2012); A guide to reflective career counselling. DVD. Randburg: Jopie van Rooyen & Partners (2012).
Prof Maree tree gereeld as hoofspreker op en is genooi om die Internasionale Kongres vir Toegepaste Sielkunde (International Congress of Applied Psychology) oor die huidige stand van dié vakgebied toe te spreek. Hierdie spoggeleenheid op die internasionale sielkundekalender vind vanaf 8 tot 13 Julie 2014 in Parys, Frankryk plaas. Hy sal by die geleentheid oor die onderwerp ‘Connecting life-themes to construct self-portraits’ praat.
Prof Maree ke profesa ka Kgorong ya Saekholotši ya Thuto ka Lefapheng la Thuto. Kgahlego ya nyakišišo ya gagwe ya motheo ke mošomo (wa go aga) keletšo le go beakanya bophelo le go aga. O kgokaganya dipoelo tša nyakišišo le kgetho ya mošomo wa maleba le kago le go beakanya bophelo le go aga.
Ke morulaganyi wa maloba wa Tšenale ya Saekholotši ya Afrika Borwa (South African Journal of Psychology), morulaganyimmogo wa Tšenale ya Saense le Theknolotši ya Afrika Borwa (SA Journal of Science and Technology ) le leloko la mekgatlo ye mmalwa ya gae le ya ditšhabatšhaba, o ngwadile diathekele tšeo di lekotšwego ke badirišane tša go feta tše 120 le dipuku tše goba dikgaolo tša dipuku tše 60 go tloga mathomong a 2004. Ka 2009 o amogetše Sefoka sa Stals sa Suid-Afrikaanse Akademie vir Wetenskap en Kuns sa nyakišišo ye botse le tema yeo a e kgathilego go saekolotši. O filwe metale wa Mokhanseliri wa go Ruta le go Ithuta ke Yunibesithi ya Pretoria ka 2010. O amogetše tekanyo ya B3 go tšwa go NRF.
Diphatlalatšo tša Prof Maree tše dintši ša kgauswinyane di akaretša: Counselling for career construction: connecting life themes to construct life portraits. Turning pain into hope. Rotterdam: Sense (2013); ‘Career-Adapt-Abilities Scale: South African form: psychometric properties and construct validity’, Journal of Vocational Behaviour, doi: 10.1016/j.jvb.2012.01.005 (2012); A guide to reflective career counsellin. DVD. Randburg: Jopie van Rooyen & Partners (2012).
Mmoledi wa notetheo wa nako le nako, Prof Maree o laleditšwe go ba Mmoledi wa Maemo a Saense mo Khonkreseng ya Ditšhabatšhaba ya Saekholotši ya Tirišo, moletlo wa sefoka sa tšhupamabaka ya saekholotši ya ditšhabatšhaba, yeo e tlo swarwago go tloga ka la 8 go fihla ka la 9 Phupu 2014 kua Paris. Mo lebakeng le o tla bolela ka ‘Connecting life-themes to construct self-portraits’

Prof Zander Myburg
Prof Myburg is professor in Genetics in the Faculty of Natural and Agricultural Sciences. He holds the Chair in Forest Genomics and Biotechnology and directs the Forest Molecular Genetics Programme, which forms part of the research portfolio of the Forestry and Agricultural Biotechnology Institute (FABI) and the Genomics Research Institute at UP. Prof Myburg’s research focuses on the genomics and molecular genetics of wood development in fast-growing forest trees, particularly on the genetic regulation of biopolymer synthesis in wood fibre cells.
His research group isolated and characterised the cellulose synthase (CesA) genes of Eucalyptus trees and is working actively on unravelling the complex transcriptional network that regulates the expression of these and other cell wall biosynthesis genes. Prof Myburg’s research team produced the first gene expression atlas of a Eucalyptus tree and produced a high-density genetic map of the Eucalyptus genome, which now serves as a framework for identifying genetic loci associated with growth and wood biomass traits. Over the past four years the work has been expanded to include the xylem transcriptomes and metabolomes of more than 280 Eucalyptus trees, which allows the application of systems genetics approaches in studying the genetic control of wood formation in these trees.
Prof Myburg is the coordinator of the international Eucalyptus Genome Network (EUCAGEN) and the lead investigator of the US Department of Energy (DOE) Eucalyptus Genome Project. He has supervised 30 postgraduate (MSc and PhD) students and is author of 47 peer-reviewed papers and book chapters in the field of plant molecular genetics and genomics. He is currently a B3 NRF rated researcher. As a recipient of a Fulbright scholarship for his PhD study at North Carolina State University in the USA (1996–2001), Prof Myburg subsequently joined the Department of Genetics at UP. In 2007, he was awarded the Southern Africa Association for the Advancement of Science (S2A3) British Association Silver Medal and he received the NRF President’s Award for Young Researchers. In 2008, the University recognised him as one of its 100 Leading Minds in its centenary year.
Prof Myburg is professor in Genetika in die Fakulteit Natuur- en Landbouwetenskappe. Hy beklee die Leerstoel vir Bosbougenomika en Biotegnologie en is direkteur van die Molekulêre Genetiese Program vir Bosbou, wat deel uitmaak van die navorsingsportefeulje van UP se Instituut vir Bosbou- en Landbou-biotegnologie (FABI) en die Genomikanavorsingsinstituut. Prof Myburg se navorsing is toegespits op die genomika en molekulêre genetika van houtontwikkeling in snelgroeiende woudbome, en veral die genetiese regulering van biopolimeersintese in houtsweefselselle.
Sy navorsingsgroep het die sellulose-sintase-gene (CesA-gene) in Eucalyptus-bome geïsoleer en beskryf. Hulle werk ook aktief aan die ontrafeling van die komplekse transkripsienetwerk wat die uitdrukking van hierdie en ander gene vir selwandbiosintese reguleer. Prof Myburg se navorsingspan het die eerste geenuitdrukkingsatlas van ʼn Eucalyptus-boom saamgestel en ʼn hoë-digtheid genetiese kaart van die Eucalyptus-genoom geskep. Dié genetiese kaart dien tans as raamwerk vir die identifisering van genetiese lokusse wat met groei en die biomassa-eienskappe van hout geassosieer word. Die groep se werk is oor die afgelope vier jaar uitgebrei om die xileem-transkriptome en metabolome van meer as 280 Eucalyptus-bome in te sluit, wat dit moontlik maak om stelselgenetiese benaderings te volg wanneer die genetiese beheer van houtvorming in hierdie bome bestudeer word.
Prof Myburg is die koördineerder van die internasionale Eucalyptus Genome Network (EUCAGEN) en die hoofnavorser van die Eucalyptus Genome Project van die Departement van Energie in die VSA. Hy het as studieleier vir 30 nagraadse studente (MSc en PhD) opgetree en is die outeur van 47 portuurbeoordeelde referate en hoofstukke in boeke oor die molekulêre genetika en genomika van plante. Die NNS het ’n B3-gradering aan hom toegeken. Ná die voltooiing van sy PhD-studie as ’n Fulbright-beurshouer aan North Carolina State University, VSA (1996–2001) het prof Myburg by UP se Departement Genetika aangesluit. In 2007 is die British Association Medal (Silwer) deur die Suider-Afrikaanse Vereniging vir die Bevordering van die Wetenskap (Southern Africa Association for the Advancement of Science – S2A3) aan hom toegeken, en het hy ook die NNS se Presidentstoekenning vir Jong Navorsers ontvang. In 2008, UP se eeufeesjaar, is hy as een van die Universiteit se 100 Denkleiers aangewys.
Prof Myburg ke profesa ya leabela mo Lefapheng la Disaense tša Tlhago le Temo. Ke modulasetulo wa Ditšenomiki tša Dikgwa le Payotheknolotši gomme o hlahlile Lenaneo la Leabela la Molekhula wa Dikgwa, yeo e lego karolo ya potfolio ya nyakišišo ya Institute ya Payotheknolotši ya Kagodikgwa le Temo le Institute ya Nyakišišo ya Tšenomiki mo UP. Nyakišišo ya Prof Myburg e nepiša ditšenomiki le molekhula wa tšweletšopele ya kota mo sekgweng sa mehlare yeo e golago ka lebelo, kudu taolong ya leabela la tlemaganyo ya payopholima mo diseleng tša lenti la kota.
Sehlopha sa gagwe sa nyakišišo se beetše thoko le go fapantšha leabela la senthase ya selulose (cellulose synthase (CesA) la mehlare ya Eucalyptus gomme e šoma ka mafolofolo go letefetša peakanyo ya bothata ya phetogo ya leabela yeo e laolago ponagalo ya disele tše dingwe le tlemaganyo ya leabela. Sehlopha sa nyakišišo sa Prof Myburg se tšweleditše leabela la mathomo la ponagalo ya atlase ya mohlare wa Eucalyptus gomme ya tšweletša mmepe wa leabela la teteano ya godimo wa tšenome ya Eucalyptus, tšeo ga bjale di šomago bjalo ka tlhako ya go hlaola leabela la loci leo le amanago le go gola le semelo sa kota ya biomase. Mo mengwageng ye mene ya go feta mošomo o godišitšwe go akaretša xylem transkriptomese le metabolomese tša mehlare ya Eucalptus ya go feta 280, yeo e dumelelago tirišo mekgwa ya tlhakego ya leabela ge go ithutwa taolo ya leabela ya tshedimošo ya kota mo mehlareng ye.
Prof Myburg o kopanya Dihlopha tša Tšenome ya Eucalyptus ya Ditšhabatšhaba gomme ke moetapele wa nyakišišo ya Protšeke ya Tšenome ya Eucalptus ya Kgoro ya Enetši ya US. O lekotše baithuti ba boalogaboglowane ba ba 30 (MSc le PhD) gomme a ngwala dipampiri tšeo di lekotšwego ke badirišane le dipuku le dikarolo tša dipuku tše 47 mo lehlakoreng la leabeleng le tšenomiking ya molekhula wa dimela. Ga bjale o na le tekanyo ya B3 ya NRF. Ke moamogedi wa thušo ya mašeleng a dithuto ya Fulbright ya go mo thekga dithutong tša gagwe tša PhD mo Yunibesithing ya Mmušo ya North Caroline (1996 go fihla ka 2001), Prof Myburg o kopane le Kgoro ya Leabela ya UP. Ka 2007 o abetšwe Metale wa Mokgatlo wa Britain (Silibere) (British Association Medal) ke Mokgatlo wa Afrika Borwa wa Tšweletšopele ya Saense (S2A3) gape o amogetše Sefoka sa Presidente sa Banyakišiši ba Baswa sa NRF. Ka 2008, ge Yunibesithi e keteka matswalo a yon, Prof Myburg o lemogilwe bjalo ka yo mongwe wa ba bangwe ba 100 ba Menagano ya Maphefo 100.

Prof Odendaal is professor in the Department of Electrical, Electronic and Computer Engineering in the Faculty of Engineering, the Built Environment and Information Technology and director of the Centre for Electromagnetism.
His research effort is focused on achieving a high level of excellence in electromagnetic technology, particularly in the design, development and evaluation of microwave antennas, radar backscatter and antenna measurements. He has developed various novel antenna radiating elements, as well as feeding and matching techniques with specific application in wireless and array technology. He has contributed to the practical implementation of polarisation optimisation for conformal antenna arrays. He has proposed various computational improvements to the edge diffraction model for a standard gain pyramidal horn antenna. He has developed sound theoretical foundations for accurate gain measurements in the compact antenna test range and radiated field densities with application to the traceable calibration of microwave field probes.
He is a senior member of the Institute of Electrical and Electronic Engineers (IEEE) and the South African Institute of Electrical Engineers, and a member of the Antenna Measurement Techniques Association (AMTA).
Prof Odendaal has authored and co-authored more than 60 articles in international peer-reviewed journals and presented 48 papers at international conferences.
Prof Odendaal holds a B3 rating from the NRF.
Prof Odendaal is professor in die Departement Elektriese, Elektroniese en Rekenaar-Ingenieurswese in die Fakulteit Ingenieurswese, Bou-omgewing en Inligtingtegnologie, asook direkteur van die Sentrum vir Elektromagnetisme.
Sy navorsing is toegespits op die bereiking van ʼn hoë vlak van uitmuntendheid op die gebied van elektromagnetiese tegnologie, veral ten opsigte van die ontwerp, ontwikkeling en evaluering van mikrogolfantennes, radarverstrooiing en antenne-afmetings. Hy het verskeie nuwe antenne-stralingselemente, asook voer- en pastegnieke met spesifieke toepassing op die gebied van radio- en samestellingstegnologie ontwikkel en het ook bygedra tot die praktiese implementering van polariseringsoptimisering vir konforme antennesamestellings. Daarbenewens het hy met verskeie numeriese verbeteringe aan die wig-diffraksiemodel vir ʼn standaard-aanwins piramidale horingantenne vorendag gekom en grondige teoretiese grondslae vir akkurate antenne-aanwinsmetings in die toetsveld vir kompakte antennes, asook vir stralingsvelddigthede met toepassing in die naspoorbare kalibrasie van mikrogolf-veldtasters ontwikkel.
Hy is ʼn senior lid van die Institute of Electrical and Electronic Engineers (IEEE) en die Suid-Afrikaanse Instituut van Elektriese Ingenieurs, en ʼn lid van die Antenna Measurement Techniques Association (AMTA).
Prof Odendaal is die outeur of medeouteur van meer as 60 artikels wat in internasionale portuurbeoordeelde joernale verskyn het en het 48 referate by internasionale konferensies aangebied.
Prof Odendaal het ’n B3-gradering van die NNS ontvang.
Prof Odendaal ke profesa ka Kgorong ya Mohlagase, Elektroniki le Boentšenere bja Dikhomputha ka Lefapheng la Boentšenere, Tikologo ya Kago le Theknolotši ya Tshedimošo le molaodimogolo wa Senthara ya Elektromaknethisemo.
Maitekelo a gagwe a nyakišišo a nepiša go hwetša legato la godimo la bokgoni ka theknolotši ya elektromaknetiki, kudu ka moakanyetšo, tšweletšopele le tekanyetšo ya dinakana tša maekroweibe, pekskata ya rada le ditekanyo tša dinakana. O tšweleditše dielemente tša mehuta ya go fapana ya dinakana tša radietara, gammogo le dithekniki tša go fepa le go swantšha ka tirišo ye e itšego mo go theknolotši ya seyalemoya le ya sehlopha. O kgathile tema go tirišo ya gore phoulareseišene e be le mohola go dihlopha tša dinakana. O akantše dikaonafatšo tša khomphuthišenale ya mokgwa wa go phatlalala ya dinakana tša go lekanela tša paramitale. O tšweleditše motheo wo o kwgalago wa teori go lekanetša mohlwaela wa teko ya dinakana, le lehlakore la bokoto bja radietara mo tirišong ya go hwetša dipropo lehlakoreng la maekroweibe.
Ke lelokolegolo la Institute ya Boentšenere bja Mohlagase le Elekroniki (Institute of Electrical and Electronic Engineers (IEEE)) gape ke leloko la Mokgatlo wa Dithekniki tša Tekanetšo ya Dinakana (Antenna Measurement Techniques Association).
Prof Ondendaal o ngwadile le go ngwalammogo dipampiri tša go feta tše 60 tša ditšhabatšhaba, tša go lekolwa ke badirišane gomme o tšwelelditše dipampiri tše 48 tša dikhonferense tša ditšhabatšhaba.
Prof Odendaal o na le tekanyo ya B3 ya NRF.

Prof Roux is professor in the Forestry and Agricultural Biotechnology Institute (FABI) and the Department of Microbiology and Plant Pathology in the Faculty of Natural and Agricultural Sciences. Her research focuses on issues of tree health, particularly fungal pathogens and their insect associates. Key research areas include mycology, plant pathology and investigations into the ecology of fungal, insect and tree interactions.
She is responsible for training postgraduate students and doing research and extension. She serves on the management committees of the Tree Protection Cooperative Programme (TPCP) and the Department of Science and Technology (DST)/ NRF Centre of Excellence in Tree Health Biotechnology (CTHB) in FABI. She also serves on the extended board of the International Union of Forestry Research Organizations (IUFRO), is vice-president of the Southern African Society for Plant Pathology and a member of the Governing Council of the Commonwealth Forestry Association.
Prof Roux has published more than 110 research papers in ISI-rated journals and serves on the editorial boards of three international scientific journals. She has received numerous awards for her research accomplishments, including the Queen’s Award for Forestry from the Commonwealth Forestry Association (2011), the DST’s Women in Science Award (2011) and the National Science and Technology Forum (NSTF) Award for Outstanding Contribution to Capacity Building in Science, Engineering, Technology and Innovation in 2012.
Prof Roux holds a B2 rating from the NRF and is an honorary member of the Chinese Academy of Forestry. She has a passion for promoting an understanding of tree health issues, particularly in Africa, and has supervised 20 PhD students in this field, many of whom came to the University of Pretoria from other African countries.
Prof Roux is professor in die Instituut vir Bosbou- en Landboubiotegnologie (FABI) en die Departement Mikrobiologie en Plantpatologie in die Fakulteit Natuur- en Landbouwetenskappe. Haar navorsing is op boomgesondheid toegespits, veral op swampatogene en die insekte wat daarmee geassosieer word. Sleutelnavorsingsgebiede sluit mikologie, plantpatologie en ondersoeke na die ekologie van die interaksies tussen swamme, insekte en bome in.
Sy is verantwoordelik vir nagraadse opleiding, navorsing en voorligting. Sy dien in die bestuurskomitees van die Koöperatiewe Program vir Boombeskerming (Tree Protection Co-operative Programme (TPCP)) en die Departement van Wetenskap en Tegnologie (DWT)/NNS se Sentrum vir Uitnemendheid in Boomgesondheidbiotegnologie (Centre of Excellence in Tree Health Biotechnology (CTHB)), wat albei in FABI gesetel is. Sy dien ook in die uitgebreide raad van die International Union of Forestry Research Organisations (IUFRO), visepresident van die Suider-Afrikaanse Vereniging vir Plantpatologie en ’n lid van die Commonwealth Forestry Association se bestuursraad.
Prof Roux het meer as 110 navorsingsartikels in ISI-gegradeerde vaktydskrifte gepubliseer en dien in die redaksionele rade van drie internasionale vaktydskrifte. Sy het talle toekennings vir haar navorsingsprestasies ontvang, insluitend die Queen’s Award for Forestry van die Commonwealth Forestry Association (2011), die DWT se Women in Science Award (2011) en die Nasionale Wetenskap- en Tegnologieforum (NSTF) se Toekenning vir Uitstaande Bydrae tot Kapasiteitsbou in Wetenskap, Ingenieurswese, Tegnologie en Innovasie (2012).
Prof Roux het ’n B2-gradering van die NNS ontvang en is ʼn erelid van die Sjinese Bosbou-akademie. Sy het ʼn passie vir die bevordering van begrip van kwessies wat boomgesondheid raak, veral in Afrika. Sy het as studieleier opgetree vir meer as 20 PhD-studente wat hierdie studierigting by UP gevolg het en waarvan baie uit ander Afrikalande afkomstig was.
Prof Roux ke profesa mo Instituting ya Payotheknolotši ya Kagodikgwa le Temo (Forestry and Agricultural Biotechnology Institute (FABI)) Nyakišišo ya gagwe e nepiša maphelo a mehlare, kudu phatotšene ya fankase le dikhunkhwane tšeo di amanago le yona. Dintlha tša bohlokwa di nepiša maekolotši, phatolotši ya dimela le nyakišišo ka ekolotši ya fankase, dikhunkhwane le tsenelano ya mehlare.
O na le maikarabelo a go hlahla baithuti ba dialogadigilwane le go dira nyakišišo le katološo. O thuša dikomiting tša bolaodi tša Lenaneo la Tirišano la Tšhireletšo ya Mehlare (Tree Protection Cooperative Programme (TPCP)) le Kgoro ya Saense le Theknolotši/Senthara ya Bokgoni ya NRF ya Payotheknolotši ya Maphelo a Mehlare ka FABI. O thuša gape makgotleng ao a okeditšwego a Mekgatlo ya Kopano ya Ditšhabatšhaba ya Nyakišišo ya Kagodithokgwa (International Union of Forestry Research Organizations (IUFRO), ke motlatša-presidente wa Lekgotla la Afrika Borwa la Phatolotši ya Dimela gape ke leloko la Khansele ye e Bušago ya Mokgatlo wa Kagodithokgwa wa Kgweranoditšhaba.
Prof Roux o phatlaladitše dipampiri tša nyakišišo tša go feta 110 ka tšenaleng ye e lekanyeditšwego ke ISI gomme o thuša makgotleng a barulaganyi a ditšenela tša saense tša ditšhabatšhaba. O amogetše difoka tše mmalwa tša dinyakišišo tša gagwe tše di atlegilego, go akaretša Sefoka sa Kgošigadi ya Kagodithokgwa go tšwa Mokgatlo wa Kagodithokgwa wa Kgweranoditšhaba (2011) le Sefoka sa Foramo ya Naga ya Saense le Theknolotši ya Seabe sa gagwe go Ageng Bokgoni bja Saense, Boentšenere, Theknolotši le Kaonafatšo ka 2012.
Prof Roux o na le tekanyo ya B2 go tšwa NRF gomme ke leloko la tlhompho la Akademi ya Kagodithokgwa ya China. O na le lerato la kgodišo le kwešišo ya ditaba tša maphelo a mehlare, kudu ka Afrika, gomme o lekotše baithuti ba 20 ba PhD ka lehlakoreng, ba bantši ba bona ba tlile Yunibesithing ya Pretoria go tšwa dinageng tše dingwe tša Afrika.

This award is given to exceptional achievers in the field of research, as seen against the University’s strategic goals of achieving academic excellence, international competitiveness and local relevance. Any person who has been evaluated by the NRF as a P-rated researcher automatically enjoys Exceptional Young Researcher status.
Hierdie toekenning word op grond van uitnemende prestasie op die gebied van navorsing gemaak, gesien in die lig van die Universiteit se strategiese doelwitte van akademiese uitnemendheid, internasionale mededingendheid en plaaslike relevansie. Enige persoon wat deur die NNS as ‘n P-gegradeerde navorser geëvalueer word, verkry outomaties die status van ‘n Uitnemende Jong Navorser.
Banyakišiši ba baswa ba go Atlegilego go fetišaSefoka se se abelwa baatlegi ba go tšwelela ka magetla lekaleng la dinyakišišo, bjalo ka ge go laeditšwe ka lenaneong la maano a Yunibesithi a go fihlelela bothakga, phenkgišano ya boditšhabatšhaba le maswanedi a selegae. Motho mang le mang yo a l ekotšwego ke NRF bjalo ka monyakišiši wa maemo P o kgotsofatša dinyakwa tša gotsenela legoro la Monyakišiši o Moswa wa go atlega go fetiša.

Prof Celia Abolnik
Prof Abolnik is associate professor in the Department of Production Animal Studies in the Faculty of Veterinary Science. She joined the University in August 2012 and holds the Poultry Research Chair of the Southern African Poultry Association. Prof Abolnik is recognised as the Southern African expert on avian influenza. For over a decade, much of her research focused on avian influenza, primarily on linking ostrich influenza to the wild duck reservoir. Since 2011 she has identified and typed all outbreak strains of avian influenza in chickens and ostriches. She remains active in influenza surveillance and diagnostics, collaborating with French scientists and the Percy FitzPatrick Institute at the University of Cape Town to gain a better understanding of the dynamics and drivers of avian influenza and the risks to poultry. Prof Abolnik’s personal research interest is the molecular basis of infection of ostriches with avian influenza and the mechanism of its conversion to the highly pathogenic form. As holder of the Poultry Research Chair she is responsible for researching not only avian influenza, but any problem affecting production in the national flock. Her background in general microbiology has been invaluable in studying other important poultry pathogens, including avian paramyxoviruses (of which Newcastle disease is one), infectious bronchitis virus, West Nile virus, mycoplasmas and the newly discovered avian gyrovirus 2 in poultry. Studies of these pathogens involve genomics, molecular epidemiology, the development of molecular and serological diagnostic tests, virus-host interactions, the emergence of host-specific and virulence factors at the quasi-species level and the dynamics of multi-pathogen infections.
She currently supervises four PhD candidates and three MSc students and manages the newly completed Poultry BSL3 facility on the Onderstepoort Campus. She has done at least 11 radio, television and print interviews on avian influenza, authored or co-authored 31 peer-reviewed scientific papers, given numerous guest lectures and is frequently invited to review scientific papers for international journals. She is the South African representative on the World Organisation for Animal Health (OIE)/Food and Agriculture Organisation of the United Nations (FAO)] OIE/FAO Network of Expertise on Animal Influenza (OFFLU) and has served on national and international task teams investigating scientific and technical issues.
Prof Abolnik is medeprofessor in die Departement Produksiedierstudies in die Fakulteit Veeartsenykunde. Sy het in Augustus 2012 by die Universiteit aangesluit en beklee die Suider-Afrikaanse Pluimveevereniging se Leerstoel vir Pluimveenavorsing. Prof Abolnik word as die vooraanstaande Suider-Afrikaanse kundige op die gebied van voëlgriep beskou. Baie van haar navorsing is reeds meer as ’n dekade lank op voëlgriep toegespits, hoofsaaklik met die doel om volstruisgriep met die wildeeendreservoir in verband te bring. Sedert 2011 het sy al die uitbreekstamme van voëlgriep by hoenders en volstruise geïdentifiseer. Sy is steeds aktief betrokke by toesig oor en die diagnose van voëlgriep en werk saam met Franse wetenskaplikes en van die Percy FitzPatrick-instituut by die Universiteit van Kaapstad ten einde ʼn beter begrip te ontwikkel en die dinamika en drywers van voëlgriep en die risiko’s wat dit vir pluimvee inhou. Prof Abolnik se persoonlike navorsingsbelangstelling is die molekulêre basis van die infektering van volstruise met voëlgriep en die meganisme waardeur dit in die uiters patogeniese vorm omgeskakel word. As bekleër van die Leerstoel vir Pluimveenavorsing is sy, benewens navorsing oor voëlgriep, ook verantwoordelik vir navorsing oor enige probleem wat produksie in die nasionale pluimveebevolking kan beïnvloed. Haar agtergrond in algemene mikrobiologie is van onskatbare waarde in die bestudering van ander belangrike patogene in pluimvee, insluitend voël-paramiksovirusse (waaronder Newcastle-siekte), infektiewe bronchitusvirus, die Wes-Nylvirus, mikoplasmas en die voël-girovirus 2 in pluimvee – ʼn onlangse ontdekking. Die studie van hierdie patogene behels genomika, molekulêre epidemiologie, die ontwikkeling van molekulêre en serologiese diagnostiese toetse, virus-gasheerinteraksies, die onstaan van gasheerspesifieke en virulensiefaktore op kwasi-spesievlak en die dinamika van multipatogeeninfeksies.
Sy tree tans op as studieleier vir vier PhD-kandidate en drie MSc-studente en bestuur die onlangs voltooide Pluimvee BSL3-fasiliteit op die Onderstepoortkampus. Sy het al aan ten minste 11 onderhoude oor voëlgriep vir radio, televisie en die gedrukte pers deelgeneem, is outeur of medeouteur van 31 portuurbeoordeelde wetenskaplike artikels, het talle gaslesings aangebied en word dikwels genooi om wetenskaplike artikels vir internasionale joernale te beoordeel. Sy is Suid-Afrika se verteenwoordiger in die OIE/FAO Network of Expertise on Animal Influenza (OFFLU) en het in nasionale en internasionale taakspanne gedien wat wetenskaplike en tegniese aangeleenthede ondersoek het.
Prof Abolnik ke mothuša profesa ka Kgorong ya Dithuto tša Tšweletšo ya Diphoofolo mo Lefapheng la Diseanse tša Bongakadiruiwa. O thomile go šomela Yunibesithi ka Phato 2012 gomme ke Modulasetulo wa Nyakišišo ya Dikgogo ya Mokgatlo wa Dikgogo wa Afrika Borwa. Prof Abolnik o tsebega bjalo ka setsebi sa Borwa bja Afrika sa mokhohlane wa dinonyana. Mo pakeng ya mengwaga ye lesome, nyakišišo ya gagwe ye ntši e nepišitše go mokhohlane wa dinonyana, gagolo go kgokaganya mokhohlane wa dimpšhe le letamo la lepidibidi la lešoka. Go tloga ka 2011 o utullotše le go gatiša ditiragalo ka moka tša mokhohlane wa dinonyana go dikgogo le dimpšhe. O dula a tšea karolo nyakišišong le ditekolong tša mokhohlane, a dirišana le boramahlale ba Sefora le Institute ya Percy FitzPatrick ya Yunibesithi ya Cape Town go hwetša kwešišo ya dilo tšeo di hlolago gape di hlohleletšago mokhohlane wa dinonyana le kotsi yeo o nago le yona dikgogong. Kgahlego ya nyakišišo ya Prof Abolnik ke theo ya molekula ya phetelo ya dimpšhe ke mokhohlane wa dinonyana le bomotšhene bja phetogo go mokgwa wa phatotšeniki wa godimo. Bjalo ka Modulasetulo wa Nyakišišo ya Dikgogo maikarabelo a gagwe ga se go nyakišiša fela mokhohlane wa dinonyana eupša bothata bjo bongwe le bjo bongwe bjoo bo amago tšweletšo mo sehlopeng sa dinonyana tša naga. Botšo bja gagwe ka maekropayolotši bo thušitše go ithuta diphatotšene tše dingwe tše bohlokwa tša dikgogo, go akaretša baerase ya paramikso ya dinonyana (yeo bolwetši bja Newcastle e lego bjo bongwe bja yona), baerase ya go fetela ya maswafo, baerase ya West Nile, maekhoplasmase le baerase ya dinonyane ya gyro 2 ye e sa tšogo utullwa dikgogong. Dithuto tša diphatotšene di ama ditšenomiki, epithemolotši ya molekula, tšwetšopele ya molekula le diteko tša tekolo ya serolotšikale, go tsenela ga mongae wa baerase, go tšwelela ga mongae yo a itšego le mabaka a baeralense mo legatong la mehuta ya quasi le dilo tšeo di hlolago phetelo ya diphatotšene tše dintši.
Ga bjale o lekola balekwa ba bane ba PhD le baithuti ba bararo ba MSc gomme o laola sedirišwa se seswa seo se sa tšogo fetšwa sa Dikgogo BSL3 Khampaseng ya Onderstepoort. O dirile bonnyane dipoledišano tše 11 tša radio, thelebišene le tša go gatišwa ka mokhohlane wa dinonyana, o ngwadile goba o ngwadile mmogo dipampiri tša saense tšeo di lekotšwego ke badirišane tše 31, o abile dithutofahlošo tše mmalwa gomme o laletšwa kgafetšakgafetša go lekola dipampiri tša mahlale tša ditšenale tša ditšhabatšhaba. Ke moemedi wa Afrika Borwa mo [Mokgatlo wa Lefase wa Maphelo a Diphoofolo/Mokgatlo wa Dijo le Temo wa Kopanoditšhaba] Tsenelano ya Tsebo ka Mokhohlane wa Dinonyane. Gomme o thušitše dihlophatirong tša naga le tša ditšhabatšhaba ba nyakišiša ditaba tša mahlale le tša thekniki.

Dr Inglesi-Lotz is a senior lecturer in the Department of Economics in the Faculty of Economic and Management Sciences. She co-ordinates and teaches the first-year course and has presented ad hoc short courses in Econometrics for the last four years.
She completed her undergraduate studies in 2006 at the University of Macedonia, Greece and continued with her postgraduate studies at the University of Pretoria in 2008. She received a postgraduate fellowship from the Department of Economics towards her PhD and a three-year bursary from the South African National Energy Development Institute of the Department of Energy. Her doctoral thesis was entitled ‘A sectoral benchmark-and-trade system to improve electricity efficiency in South Africa’. In 2011, she received both the Economic Research South Africa Certificate for Meritorious Performance in Economics and the Economics Head of Department Prize for achievement in Economics research at doctoral level.
Her research interests focus on energy and environmental economics, economic growth and development, and applications of time series and panel data econometrics. The Department of Economics acknowledged her as Junior Researcher of the Year in 2011 and 2013.
Dr Inglesi-Lotz is ’n senior lektor in die Departement Ekonomie in die Fakulteit Ekonomiese en Bestuurswetenskappe. Sy koördineer en bied die eerstejaarskursus aan en het die afgelope vier jaar ad hoc-kortkursusse in Ekonometrie aangebied.
Sy het haar voorgraadse studie in 2006 aan die Universiteit van Macedonië in Griekeland voltooi, waarna sy haar nagraadse studie in 2008 aan die Universiteit van Pretoria voortgesit het. Vir haar PhD het sy ʼn nagraadse genootskap van die Departement Ekonomie, asook ʼn driejaarbeurs van die Suid-Afrikaanse Nasionale Energieontwikkelingsinstituut in die Departement van Energie ontvang. Die titel van haar doktorale proefskrif was ‘A sectoral benchmark-and-trade system to improve electricity efficiency in South Africa’. In 2011 het sy twee toekennings ontvang: Ekonomiese Navorsing Suid-Afrika se Sertifikaat vir Verdienstelike Prestasie in Ekonomie en die Ekonomie-departementshoofprys vir prestasie in ekonomiese navorsing op doktorale vlak.
Haar navorsingsbelangstellings is toegespits op energie, ekonomiese groei en ontwikkeling, asook die toepassings van tydreekse en paneeldata-ekonometrie. Die Departement Ekonomie het haar in 2011 en 2013 as Junior Navorser van die Jaar aangewys.
Dr Inglesi-Lotz ke mafahlošimogolo ka Kgorong ya Ekonomi le Lefapheng la Disaense tša Ekonomi le Taolo. O kopanya le go ruta dithuto tša ngwaga wa mathomo gomme o rutile dithuto tše kopana tšeo di sa beakanywago tša ekonometriki mo mengwageng ye mene ya go feta. O feditše dithuto tša gagwe tša go boithutelatikri ya mathomo ka 2006 Yunibesithing ya Macedonia, Greece gomme a tšwela pele ka dithuto tša gagwe tša boalogabogolwane Yunibesithing ya Pretoria ka 2008.
O amogetše Tirišano ya Sealogasegolwane go tšwa Kgorong ya Ekonomi go ya mafelelong a PhD le thušo ya tšhelete ya dithuto ya mengwaga ye meraro go tšwa go Institute ya Tšweletšopele ya Enetši ya Afrika Borwa ya Kgoro ya Enetši. Thesisi ya gagwe ya bongaka e be e le, A sectoral benchmark-and-trade system to improve electricity efficiency in South Africa. Ka 2011 o amogetše ka moka Setifikeiti sa Nyakišišo ya Ekonomi ya Afrika Borwa sa Mošomo wo o rategago wa Thuto ya Ekonomi le Sefoka sa Hlogo ya Kgoro ya Thuto ya Ekonomi sa bokgoni bja nyakišišo ya ekonomi mo legatong la bongaka. Nyakišišo ya gagwe e nepiša thuto ya ekonomi ya enetši le tikologo, kgolo ya ekonomi le tšweletšopele, le ditirišo tša mohlwaela wa nako le sehlopha sa data ya ekonometriki. Ngaka Inglesi-Lotz o phatlaladitše dipampiri tše mmalwa ditšenaleng tša boditšhabatšhaba le tša gae tšeo di lekotšwego ke badirišane. Kgoro ya Thuto ya Ekonomi e mo amogela bjalo ka Monyakišiši yo mo nnyane wa Ngwaga ka 2011 le 2013.

Prof Wanda Markotter
Prof Markotter is associate professor and the research leader on bat-borne zoonotic viruses in the Viral Zoonosis Research Group in the Department of Microbiology and Plant Pathology in the Faculty of Natural and Agricultural Sciences. Her research focuses on the disease ecology, pathogenicity and diagnostics of rabies, as well as other zoonotic pathogens associated with African bat species. In this regard research has generated new knowledge on the incidence, diversity and pathogenicity of rabies-related lyssaviruses in South Africa and in other regions in Africa. Her research also reported the first characterisation of several other families of viruses associated with bat species in South Africa, including paramyxo-, corona- and filoviruses.
A new diagnostic method she developed specifically to test for African viruses that cause rabies is now used as a diagnostic method in national diagnostic reference laboratories to diagnose suspected human rabies cases and as a confirmatory method for animal rabies cases, specifically those involving degraded samples. National and international recognition for Prof Markotter’s research is reflected in her engagement with researchers from around the world and her research outputs published in high impact journals. In 2013 she was a finalist in the Women in Science and NSTF-BHP Billiton awards. Prof Markotter serves on the editorial board of the journal PLOS ONE and plays a key role in other national bodies such as the National Rabies Advisory Group. She is actively involved in creating awareness of the disease and promotes the conservation of bat species. She has served on the committee of the Gauteng and Northern Regions Bat Interest Group (GNORBIG) since 2008. Prof Markotter makes a significant contribution to the development of human capital through under- and postgraduate training. By way of national and international collaboration with science councils, institutes, museums, diagnostic facilities and other universities, students are afforded the opportunity to interact with various disciplines. She is regularly involved in training activities to build capacity in South Africa as well as Africa. She has been invited to present regional training courses in epidemiology, diagnostics and bioinformatics of diseases for the International Atomic Energy Agency, and training courses for the World Organisation for Animal Health (OIE) and for directorates of veterinary services in several African countries.
Prof Markotter is ‘n medeprofessor wat aan die hoof staan van navorsing oor soönotiese virusse wat deur vlermuise oorgedra word. Dié navorsing word deur die Navorsingsgroep oor Virale Soönoses in die Departement Mikrobiologie en Plantpatologie in die Fakulteit Natuur- en Landbouwetenskappe onderneem. Haar navorsingsfokus is die siekte-ekologie, patogenisiteit en diagnostiek van hondsdolheid, asook ander soönotiese patogene wat met Afrika-vlermuise geassosieer word. Dié navorsing het nuwe kennis oor die voorkoms, diversiteit en patogenisiteit van hondsdolheidverwante lissavirusse in Suid-Afrika en ander streke in Afrika aan die lig gebring. Op grond van haar navorsing is verskeie ander virusfamilies wat met Suid-Afrikaanse vlermuise geassosieer word, beskryf, insluitend paramikso-, corona- en filovirusse.
ʼn Nuwe diagnostiese metode wat sy ontwikkel het om spesifiek te toets vir Afrika-virusse wat hondsdolheid veroorsaak, word nou as diagnostiese metode in nasionale diagnostiese verwysingslaboratoriums gebruik om vermeende gevalle van hondsdolheid in mense te diagnoseer en hondsdolheid in diere te bevestig, veral in gevalle waar monsters gedegradeer is. Haar wye skakeling met navorsers van oral in die wêreld, asook die publikasie van haar navorsingsresultate in hoë-impak vaktydskrifte, getuig van die nasionale en internasionale erkenning wat prof Markotter se werk geniet. In 2013 was sy ʼn finalis in die Vroue in Wetenskap- en NSTF-BHP Billiton-toekennings. Prof Markotter dien op die redaksionele raad van die vaktydskrif PLOS ONE. Sy speel ʼn sleutelrol in nasionale liggame soos die Nasionale Adviesgroep oor Hondsdolheid en is aktief betrokke by die skep van bewustheid van dié siekte. Sy is ʼn voorstaander van die bewaring van vlermuisspesies en dien sedert 2008 in die komitee van die Vlermuis-belangegroep van Gauteng en die Noordelike Streke (Gauteng and Northern Regions Bat Interest Group (GNORBIG). Prof Markotter lewer ʼn noemenswaardige bydrae tot die ontwikkeling van mensekapitaal deur voor- en nagraadse opleiding. Studente word by wyse van internasionale samewerking met wetenskapsrade, institute, museums, diagnostiese fasiliteite en ander universiteite aan interaksie met verskeie vakgebiede blootgestel. Sy is gereeld betrokke by opleidingsaktiwiteite om kapasiteit in Suid-Afrika en Afrika te bou. Sy is genooi om streekopleidingskursusse in die epidemiologie, diagnostiek en bioinformatika van siektes vir die Internasionale Atoomenergieagentskap (Atomic Energy Agency) aan te bied, asook vir die Wêreldorganisasie vir Dieregesondheid (World Organisation for Animal Health (OIE) en die direktorate van veeartsenykundige dienste in verskeie Afrika-lande.
Prof Markotter ke moetapele wa nyakišišo ka dibaerase tša batpone ka Sehlopheng sa Nyakišišo sa Baerale Sonesese ka Kgorong ya Maekropaelotši le Phatolotši ya Dimela ka Lefapheng la Disaense tša Tlhago le Temo. Nyakišišo ya gagwe e nepiša bolwetši bja ekholotši, phatotšenesiti le thekolo ya bogafa bja dimpša, gammogo le diphatonotšene tše dingwe tša sonothiki tšeo di amanago le mohuta wa petša wa Afrika. Ka tsela yeo nyakišišo e tšweleditše tsebo ye mpsha ka tiragalo, phapano le phatotšenesithi tša dibaraese tša lesa tšeo di amanago le bogafa bja dimpša mo Afrika Borwa le dilete tše dingwe tša Afrika. Nyakišišo ya gagwe e begile gape pharadipataka ya tše dingwe tša malapa a mangwe a dibaraese tšeo di amanago le mohuta wo mongwe wa petša mo Afrika Borwa, go akaretša le pharamikso, korona le filobaerase.
Mohuta wo moswa wa phekolo wo a o tšweleditšego go leka dibaerase tša Afrika tšeo di hlolago bogafa bja dimpša bjale o a šomišwa mo mekgweng ya phekolo mo dilaporatoring tša boitsebišo tša setšhaba go phekola bogafa bja dimpša bathong le bjalo ka mokgwa wa kgonthišo ya bogafa bja dimpša mo diphoofolong, kudu tšeo di amanago le dišupo tšeo di fokoditšwego. Nyakišišo ya gae le ya ditšhabatšhaba ya Prof Markotter e laeditšwe ke kamano ya gagwe le banyakišiši ba bangwe go tšwa lefaseng ka moka gomme tšweletšo ya nyakišišo ya gagwe e phatlaladitšwe ka ditšenaleng tšeo di kgathago tema ye kgolo. Ka 2013 e be e le mothopasefoka mo Difokeng tša Basadi le Theknolotši le NSTF-BHP Billiton. Prof Markotter o thušitše mo lekgotleng la barulaganyi ba tšenale ya PLOS ONE gomme o ralokile karolo ye bohlokwa le mekgatlong ye mengwe ya setšhaba bjalo ka Sehlopha sa Dikeletšo sa Setšhaba sa Bogafa bja Dimpša. O tšea karolo go lemoša batho ka malwetši gomme a godiša paballo ya mehuta ya petša. O thušitše komiting ya Gauteng le Dilete tša Leboa ya Sehlopha sa Kgahlego ya Petša (Gauteng and Northern Regions Bat Interest Group (GNORBIG) go tloga ka 2008. Prof Markotter o kgathile tema ye kgolo go tšweletšopele ya letlotlo la batho ka ditlhahlo tša boithutelatikrii ya mathomo le baologabogolwane. Ka mokgwa wa gae le wa ditšhabatšhaba wa tirišano le dikhansele tša saense, diinstitute, dimuseamo, didirišwa tša phekolo le diyunibesithi tše dingwe, baithuti ba fiwa dibaka go tsenelana le dikarolo tša go fapana. Nako le nako o tšea karolo mo go hlahleng ditiro tša bokgoni mo Afrika Borwa le Afrika gomme o laleditšwe go tšweletša tlhahlo ya dithutwana tša selete ka ephitemolotši, phekolo le tshedimošophelo ya malwetši ya Mmaditsela wa Ditšhabatšhaba wa Enetši ya Atomo (International Atomic Energy Agency), gammogo le Mokgatlo wa Lefase wa Maphelo a Diphoofolo (World Organisation for Animal Health (OIE) le balaodi ba ditirelo tša bongakadiruiwa mo dinageng tše mmalwa tša Afrika.

Prof Ferdinand Meyer
Prof Meyer is the director of the Bureau for Food and Agricultural Policy (BFAP) and associate professor in the Department of Agricultural Economics, Extension and Rural Development.
Developing a strong interest in strategic decision making and scenario planning, Prof Meyer studied for his PhD at the University of Missouri where he also developed the first multimarket outlook and scenario planning model for the South African agricultural sector. He completed the PhD degree successfully in 2006.
In 2004 he established the BFAP as a research unit with the main objective of facilitating strategic decision making in agriculture. Under his leadership, the BFAP has grown into an analytical unit linking 41 analysts and researchers, most of whom are affiliated with the University of Pretoria, the University of Stellenbosch and the Department of Agriculture of the Western Cape. The BFAP has published ten agricultural baselines (2004–2013) in which a ten-year outlook of the agricultural industry is presented. Through the BFAP, Prof Meyer provides a service to a wide range of governmental, national and multinational companies and organisations in the agro-industrial complex and facilitates decision making through strategic analysis of markets, value chains, natural resource potential and the development of future scenarios. In recent years Prof Meyer has shifted his research and strategic focus to the African continent. He is one of the founding members of the newly formed Regional Network of Agricultural Policy Research Institutes (ReNAPRI). Prof Meyer received a Y1 rating from the NRF. Sixteen master’s and four doctoral students have graduated under his supervision. Other academic outputs include chapters in books and seven awards from the Agricultural Economics Association of South Africa (AEASA). Under Prof Meyer’s leadership, the BFAP has compiled 38 research reports. He has made 86 national and international appearances as invited speaker at conferences. Having served on the National Crop Estimates Committee, he is a current board member of the Protein Research Foundation (PRF) and of ReNAPRI.
Prof Meyer is die direkteur van die Buro vir Voedsel- en Landboubeleid (BFAP) en medeprofessor in die Departement Landbou-ekonomie, Voorligting en Landelike Ontwikkeling.
Gedurende sy PhD-studies aan die Universiteit van Missouri het hy ’n sterk belangstelling in strategiese besluitneming en scenariobeplanning ontwikkel. Dit is dan ook waar hy die eerste multimarkbeskouing en scenariobeplanningsmodel vir die Suid-Afrikaanse landbousektor ontwikkel het. ’n PhD-graad is in 2006 aan hom toegeken.
In 2004 het hy die BFAP as ’n navorsingseenheid gestig. Die hoofdoel daarvan was om strategiese besluitneming op landbougebied te fasiliteer. Onder sy leiding het die BFAP ontwikkel tot ’n analitiese eenheid wat 41 ontleders en navorsers, wat hoofsaaklik by die Universiteit van Pretoria, die Universiteit van Stellenbosch en die Departement Landbou in die Wes-Kaap geaffilieer is, byeenbring. Die BFAP het tien landbougrondlyne gepubliseer (2004–2013) wat ’n vooruitbeskouing van die landbounywerheid oor die volgende tien jaar bied. Deur middel van die BFAP bied prof Meyer ’n diens aan ’n groot aantal staats-, nasionale en internasionale maatskappye en organisasies in die landbou-industriële sektor en fasiliteer hy besluitneming deur die strategiese ontleding van markte, waardekettings en natuurlike hulpbronpotensiaal, asook die ontwikkeling van toekomsscenario’s. Oor die afgelope paar jaar het prof Meyer sy navorsing en strategiese fokus na die vasteland van Afrika verskuif. Hy is een van die stigterslede van die nuut gestigde Streeksnetwerk van Landboubeleidsnavorsingsinstitute (ReNAPRI). Prof Meyer het ’n Y1-gradering van die NNS ontvang. Sestien meesters- en vier doktorale studente het reeds onder sy leiding gegradueer. Ander akademiese uitsette sluit hoofstukke in boeke in en sewe toekennings van die Landbou-ekonomiese Vereniging van Suid-Afrika (AEASA). Onder prof Meyer se leiding het die BFAP 38 navorsingsverslae opgestel. Hy het as ’n genooide spreker by 86 nasionale en internasionale konferensies opgetree. Hy het in die Nasionale Oesskattingskomitee gedien, en is tans ’n raadslid van die Proteïennavorsingstigting (PRF) en van ReNAPRI.
Prof Meyer ke molaodimogolo wa Biro ya Dijo le Pholisi ya Temo mo Yunibesithing ya Pretoria le mothuša profesa ka Kgorong ya Ekonomi ya Temo, Katološo le Tšweletšopele ya Magae.
Go tšweletša pele kgahlego ya go tia ka diphetho tšeo di beakantšwego peakanyo ya senario, Prof Meyer o ithutetše PhD ya gagwe Yunibesithing ya Missouri moo a tšweleditšego pele pono ya mebaraka ye e fapanego le mmotlolo wa peakanyo ya scenario wa karolo ya temo ya Afrika Borwa. O feditše tikrii ya PhD ka katlego ka 2006.
Ka 2004 o hlomile BFAP bjalo ka yuniti ya nyakišišo ka maikemišetšo a magolo a go nolofatša diphetho tšeo di beakantšwego tša temo. Ka fase ga bolaodi bja gagwe BFAP e gotše ya ba yuniti ya tlhopollo e kopanya bahlopolli le banyakišiši ba 41 ba bontši bja bona ba tswalane le Yunibesithi ya Pretoria, Yunibesithi ya Stellenbosch goba Kgoro ya Temo ya Western Cape. BFAP e phatlaladitše methalotheo ya temo ye lesome (2004 go fihla ka 2013) moo pono ya mengwaga ye lesome ya intasteri ya temo e kgadilwego. Ka BFAP, Prof Meyer o abile tirelo mmušong, dikhampaning tša setšhaba le setšhabantši le mekgatlo ka intastering ya tharagano ya temo le go tšea sephetho ka dinolofatši go dira dipheto tše di beakantšwego tša mebaraka, mohola, le mohlwaela wa ditiro, kgonagalo ya methopo ya tlhago le tšweletšopele ya disenario tša ka moso. Mo mengwageng ya bjale Prof Meyer o šutišitše nyakišišo ya gagwe le nepišo ye e beakantšwego go kontinente ya Afrika. Ke o mongwe wa maloko ao a hlomilego Diinstitute tša Dinyakišišo tša Marangrang a Selete a Pholisi ya Setšhaba ya Temo (Regional Network of Agricultural Policy Research Institutes (ReNAPRI) tše di sa tšogo hlongwa tše dimpsha. Prof Meyer o amogetše tekanyo ya Y1 ya NRF. Baithuti ba lesometshela le ba bane ba bongaka ba alogile ka fase ga tebelelo ya gagwe. Ditšweletši tša gagwe tše dingwe tša thuto di akaretša dikgaolo tša dipuku le difoka tše šupa go tšwa Mokgatlong wa Diekonomi tša Temo tša Afrika Borwa (Agricultural Economics Association of South Africa (AEASA). Ka fase ga bolaodi bja Prof Meyer, BFAP e beakantše dipego tša dinyakišišo tše 38. O tšweletše makga a 86 setšhabeng le ditšhabatšhabeng bjalo ka seboledi se se laleditšwego mo dikhonferenseng. Ka ge a ile a thuša Komiting ya Setšhaba ya Ditekanyetšo tša Puno, ga bjale ke leloko la lekgotla la Motheo wa Nyakišišo ya Proteine (Protein Research Foundation (PRF)) le Diinstitute tša Dinyakišišo tša Marangrang a Selete a Pholisi ya Setšhaba ya Temo (Regional Network of Agricultural Policy Research Institutes (ReNAPRI).

Prof Elmar Venter
Prof Venter is associate professor in the Department of Taxation in the Faculty of Economic and Management Sciences and is a qualified chartered accountant. His current research focuses on the regulatory and capital market effects of the earnings figures of firms that do not conform to Generally Accepted Accounting Practice (GAAP). In September 2011, Prof Venter completed his PhD in Accounting at the University of Auckland, rated the 20th best university in the world for Accounting and Finance. He received a full scholarship from the Business School of the University of Auckland to complete this PhD.
During 2013, he was internationally recognised with an extremely prestigious award when he became one of only five emerging researchers from across the globe to be invited to join the Deloitte and International Association for Accounting Education and Research Scholarship Programme. The programme has made it possible for him to attend conferences in Germany, France, Romania and the USA. He was a visiting scholar at the Stanford Graduate School of Business during February 2014.
Prof Venter is a co-editor of Meditari Accountancy Research and has published in leading international accounting and finance journals. In 2013 he published ‘Mandatory earnings disaggregation and the persistence and pricing of earnings components’ (co-authored by S F Cahan and D Emanuel, University of Auckland) in The International Journal of Accounting and ‘The accounting profession’s influence on academe: South African evidence’ (co-authored by C de Villiers, University of Waikato) in Accounting, Auditing and Accountability Journal. During 2014 he published ‘The value relevance of mandatory non-GAAP earnings’ (co-authored by S F Cahan and D Emanuel) in Abacus
Prof Venter is medeprofessor in die Departement Belasting in die Fakulteit Ekonomiese en Bestuurswetenskappe en ʼn gekwalifiseerde geoktrooieerde rekenmeester. Sy huidige navorsing fokus op die regulatoriese en kapitaalmarkeffekte van die inkomstesyfers van firmas wat nie aan die Algemeen Aanvaarde Rekeningkundige Praktyk (AARP) voldoen nie. Prof Venter het sy PhD in Rekeningkunde in September 2011 aan die Universiteit van Auckland behaal. Dié universiteit word as die 20ste beste universiteit ter wêreld vir onderrig in Rekeningkunde en Finansies beskou. Die Universiteit van Auckland se Sakeskool het prof Venter se PhD ten volle gefinansier.
In 2013 het hy internasionale erkenning verwerf toe hy as een van slegs vyf opkomende navorsers ter wêreld genooi is om by die Deloitte and International Association for Accounting Education and Research Scholarship Programme aan te sluit –ʼn hoog aangeskrewe toekenning wat hom in staat gestel het om konferensies in Duitsland, Frankryk, Roemenië en die VSA by te woon. In Februarie 2014 was hy ʼn besoekende vakkundige aan die Stanford Nagraadse Sakeskool.
Prof Venter is ʼn mederedakteur van Meditari Accountancy Research en sy werk is al in vooraanstaande internasionale rekeningkundige en finansiële vaktydskrifte gepubliseer. In 2013 het The International Journal of Accounting die artikel ‘Mandatory earnings disaggregation and the persistence and pricing of earnings components’ (wat hy in samewerking met S F Cahan en D Emanuel van die Universiteit van Auckland geskryf het) gepubliseer. Nog ’n artikel, ‘The accounting profession’s influence on academe: South African evidence’ (met C de Villiers van die Universiteit van Waikato as medeouteur), het in Accounting, Auditing and Accountability Journal verskyn. In 2014 het hy ‘The value relevance of mandatory non-GAAP earnings’ (met S F Cahan en D Emanuel as medeouteurs) in Abacus gepubliseer.
Prof Venter ke mothuša profesa ka Kgorong ya Motšhelo ka Lefapheng la Disaense tša Ekonomi le Taolo gomme ke Sebalamatlotlo seo se kgonago. Nyakišišo ya gagwe ya bjale e nepiša dipheto tša melao le mmaraka wa letlotlo ya palo ya letlotlo ya difeme tšeo di sa latelego Tirišo ya Kakaretšo yeo e Amogelegago ya Sešupatlotlo. Ka Lewedi 2011, Prof Venter o feditše PhD ya gagwe ya Sešupatlotlo Yunibesithing ya Auckland, e lekanyeditšwe go ba Yunibesithi ya bo 20 ye kaone lefaseng ka Sešupatlotlo le Tšhelete. O amogetše thekgo ya tšhelete ya dithuto go tšwa Sekolong sa Kgwebo sa Yunibesithi ya Auckland gore a feleletše PhD ya gagwe.
Ka 2013, o lemogilwe ke ditšhabatšhaba ge a eba o mongwe wa banyakišiši bao ba tšweletšego pele lefaseng bao ba laleditšwego go tsenela Mokgatlo wa Deloitte le Mokgatlo wa Ditšhabatšhaba wa Thuto ya Sešupatlotlo le Lenaneo la Thekgo ya Tšhelete ya Dithuto tša Nyakišišo, sefoka se bohlokwa. Lenaneo le mo kgontšhitše go tsenela dikonferense Germany, France, Romania le United States. E be e le moithuti wa moeng Sekolong sa Dialoga tša Kgwebo sa Stanford ka Dibokwane 2014.
Prof Venter ke morulaganyimmogo wa Meditari Accountancy Research, gomme o phatlaladitše ka ditšenaleng tša ketapele tša ditšhabatšhaba tša sešupatlotlo le tšhelete. Ka 2013 o phatlaladitše ‘Mandatory earnings disaggregation and the persistence and pricing of earnings components’ (bangwadimmogo ke S F Cahan le D Emanuel, Yunibesithi ya Auckland) ka go The International Journal of Accounting le The International Journal of Accounting le ‘The accounting profession’s influence on academe: South African evidence’ (o ngwadile mmogo le C de Villiers, University of Waikato) in the Accounting, Auditing and Accountability Journal. Ka 2014, o phatlaladitše ‘The value relevance of mandatory non-GAAP earnings’ (bangwadimmogo ke S F Cahan le D Emanuel) ka Abacus

Dr Chris Weldon
Dr Weldon is a lecturer in the Department of Zoology and Entomology in the Faculty of Natural and Agricultural Sciences. Awarded a PhD from the University of Sydney in 2005, he joined the University of Pretoria in 2012 after holding postdoctoral positions at Macquarie University in Australia and at Stellenbosch University.
Dr Weldon has diverse skills and experience in entomology, with a research background that encompasses insect behaviour, ecology and physiology, particularly in relation to tolerance of environmental stress and the fitness consequences of diet. Much of his research output can be applied to the control of serious insect pests, including tephritid fruit flies, while also addressing important, fundamental biological questions.
Tephritid fruit flies are recognised globally as destructive horticultural pests that constitute an enormous economic burden because of lost productivity, the costs of pest control and trade barriers. Dr Weldon’s research has provided tangible benefits for the management of these pests using the sterile insect technique by optimising the radiation dose used to sterilise flies, which ensures that released sterile flies are capable of withstanding natural conditions, and improving sterile male performance by manipulating their pre-release diet. In so doing, Dr Weldon has contributed to the debate on the relative contribution of energy intake and nutrient balance to ageing, finding that nutrients rather than caloric restriction increase lifespan.
Dr Weldon is the lead or contributing author of 26 published, peer-reviewed journal articles. His expertise in fruit fly biology has been recognised by invitations to contribute to three reviews and to provide one book chapter. To date, his publications have attracted 261 citations at an average citation rate of 32,62 per year. He has successfully supervised one PhD and four BSc Honours students, and is currently supervising three PhD, two MSc and two BSc Honours students.
Dr Weldon is ‘n lektor in die Departement Dierkunde en Entomologie in die Fakulteit Natuur- en Landbouwetenskappe. Nadat hy sy PhD-graad in 2005 aan die Universiteit van Sydney voltooi het, het hy nadoktorale posisies aan die Macquarieuniversiteit in Australië en die Universiteit van Stellenbosch beklee voordat hy in 2012 by die Universiteit van Pretoria aangesluit het.
Dr Weldon beskik oor uiteenlopende vaardighede en ervaring in entomologie. Sy navorsingsagtergrond sluit insekgedrag, -ekologie en -fisiologie in, veral met betrekking tot weerstand teen omgewingstres en die uitwerking van dieet op fiksheid. Sy navorsingsresultate kan in ʼn groot mate op die beheer van ernstige insekpeste, insluitend vrugtevlieë van die familie Tephritidae, toegepas word terwyl dit terselfdertyd ook aandag skenk aan belangrike fundamentele biologiese vrae.
Vrugtevlieë van die familie Tephritidae is wêreldwyd berug as uiters skadelike tuinboupeste wat ‘n enorme ekonomiese las meebring as gevolg van verliese aan produktiwiteit, die koste van plaagbeheer en handelsbeperkinge. Dr Weldon se navorsing hou tasbare voordele in vir die beheer van hierdie peste deur die toepassing van die steriele-insek-tegniek. Deur die bestralingsdosis te optimaliseer, verseker hy dat die vrygelate steriele vlieë in natuurlike omstandighede kan oorleef. Die vrygelate steriele mannetjies se prestasie word verbeter deur die dieet wat hulle voor vrylating volg, te manipuleer. Dr Weldon het ook bygedra tot die debat oor die relatiewe bydrae van energie-inname en voedingstofbalans tot veroudering, en het bevind dat voedingstowwe, eerder as kaloriebeperking, lewensduur verleng.
Dr Weldon is die hoof- of ʼn medeouteur van 26 gepubliseerde, portuurbeoordeelde artikels wat in vaktydskrifte verskyn het. Sy kundigheid oor en kennis van die biologie van vrugtevlieë het daartoe gelei dat hy uitnodigings ontvang het om tot drie oorsigte by te dra en een hoofstuk vir ’n boek te skryf. Tot op hede is sy publikasies 261 keer aangehaal (gemiddeld 32,62 keer per jaar). Hy was die studieleier vir een PhD- en vier BSc(Hons)-studente en tree tans op as studieleier vir drie PhD-, twee MSc- en twee BSc(Hons)-studente.
Dr Weldon ke mofahloši ka Kgorong la Zoolotši le Enthimolotši ka Lefapheng la Disaense tša Tlhago le Temo. O amogetše PhD go tšwa Yunibesithing ya Sydney, Asutralia, ka 2005, o tlile Yunibesithing ya Pretoria ka 2012 ka morago ga go hwetša maemo a ka morago ga bongaka Yunibesithing ya Australia le Yunibesithing ya Stellenbosch.
Dr Weldon o na le mabokgoni a go fapana le maitemogelo a enthimolotši, le botšo bjo bo akaretšago maitshwaro a dikhunkhwane, ekholotši le fisiolotši, kudu go amana le kgotlelelano le kgatelelo ya tikologo le ditlamorago tša tekanelo ya mmele ka dijo. Bontši bja tšweletšo ya nyakišišo ya gagwe e ka dirišwa go laola dikhunkhwane, go akaretša difofi tša dienywa, mola e fetola dipotšišo tše bohlokwa tša tlhago.
Difofi tša Seenywa sa Tephritid se lemogwa lefaseng ka moka bjalo ka tšeo di senyago tšeo di tlišago mathata a ekonomi ka lebaka la go lobja ga tšweletšo, ditshenyagelo tša taolo le thibelo ya thekišo. Nyakišišo ya Dr Weldon e na le dipoelo ka taolo ya dikhunkhwane tše go šomišwa thekniki ya go opafatša ka go kaonafatša bontšhi bja kedišo go opafatša difofi, yeo e netefatšago gore difofi tšeo di lokollwago tšeo di opafaditšwego di kgona go emela maemo a tlhago, le go kaonafatša tšhomo ya difofi tše ditona tšeo di opafaditšwego ka go huetša tokollo ya pele ga dijo. Ka go dira bjalo, Dr Weldon o kgathile tema dingangišanong tša tema yeo e kgathwago ke enetši yeo e tšewago le tekanetšo ya dijo mo bogolong, a utolla gore phepo go na le dikhalori e oketša bophelo.
Dr Weldon ke ketapela goba motšeakarolo go diphatlalatšo tše 26, tša diathekele tša tšenale tšeo di lekotšwego ke badirišane. Bokgoni bja gagwe ka thutaphedi ya difofi tša dienywa e lemogilwe ka ditaletšo go tšea karolo go ditekolo tše tharo le go ngwala kgaolo ya puku. Go fihla lehono, diphatlalatšo tša gagwe di gogile šedi ya ditsopolwa tše 261 ka palogare ya tekanyo ya ditsopolwa ya 32,62 ka ngwaga gomme ditšhupane tša gagwe ke tše 10. O lekotše ka katlego moithuti o tee wa PhD le ba ba 4 ba BSc Honours, ga bjale o lekola baithuti ba ba raro ba PhD le ba ba bedi ba MSc le ba babedi ba BSc Honours.

The Laureates are awarded to nominated projects that display teaching practices with clear purpose and intent, with strong alignment between the different elements in the broader context, that address identified needs or gaps with the aim of innovation to optimise teaching and learning. These nominations show significant evidence of impact on student learning, are sustainable and can be replicated in other contexts. These projects contribute to best practice in teaching and display significant evidence of innovation that addresses the identified challenges.
Die Laureaattoekennings word gemaak aan genomineerde projekte wat bewys lewer van onderrigpraktyke met duidelike doelwitte en opset, waarvan die verskillende elemente in die breër konteks in lyn gebring is, wat spesifieke behoeftes of gapings aanspreek en innovasie ten doel het om onderrig en leer te optimiseer. Hierdie nominasies lewer betekenisvolle bewys van impak op studente-leer, is volhoubaar en kan in ander kontekste herhaal word. Die projekte dra by tot beste praktyk in onderrig en toon innovasie wat geïdentifiseerde uitdagings aanspreek.
Difoka tša Laureate tša Bokgoni bja go Ruta le Botšo
Ba Laureates ba abetšwe go kgetho ya diprotšeke tšeo di bontšhago ditirišo tša go ruta ka maikemišetšo ao a bonagalago le go ikemišetša, ka peakanyo ya go tia gare ga dikokwane tša go fapana ditikologong ka bophara, tšeo di šoganago le dinyakwa tše di lemogilwego goba dikgoba ka maikemišetšo a botšo a go kaonafatša go ruta le go ithuta. Dikgetho tše di bontšha bohlatse bjo bohlokwa bja khuetšo mo go ithuteng ga baithuti, e a thekgwa gomme e ka dirišwa ditikologong tše dingwe. Protšeke tše di kgatha tema go tirišo ye botse ya go ruta gomme di bontšha bohlatse bjo bohlokwa go botšo bjo šoganago le ditlhotlo tše di lemogilwego.

Theresa van Oordt
Project title: ‘From accountant to educator: a non-taxing teaching journey’
Theresa Van Oordt is a senior lecturer in the Department of Taxation in the Faculty of Economic and Management Sciences. She is a qualified chartered accountant (CA(SA)) and obtained an MCom(Taxation) from the University of Pretoria in 2011. She was nominated for the award for various projects based on innovative teaching strategies. The teaching portfolio she submitted as part of her nomination included a description of her teaching philosophy and various projects she had developed throughout her teaching journey. Theresa Van Oordt implemented these projects with the support of Prof Madeleine Stiglingh, head of the Department of Taxation.
Theresa Van Oordt’s teaching philosophy is based on three principles, namely understanding student learning, curriculum development and response to employer expectations.
Recent publications
2013: Research article: ‘Including professional skills into an undergraduate taxation curriculum: a practical approach’. Theresa Van Oordt presented this as a paper at the South African Accounting Association’s International Conference held in June 2013 in Cape Town, South Africa; 2013: Co-author of research article: ‘Wholebrain facilitation of learning: two teachers are better than one’, accepted for publication in Meditari Accountancy Research, an accredited journal; 2011: Research article: ‘Facebook as an additional communication tool with large undergraduate taxation groups’ in fulfillment of the requirements for the MCom(Taxation) degree.
Comments of the evaluators and moderator
The presentation by Theresa Van Oordt was enlightening and she followed a mature approach to reflecting on her work as an accounting lecturer, teacher and educator. She teaches taxation, which is an extremely regulated module with very specific material, but she took it to the next level, really reflecting on what it means to be an educator. She did not work in isolation and managed to take the Department of Taxation with her and obtain their buy-in into a new approach to teaching taxation. She linked teaching and research and participated actively in institutional governance structures and training opportunities. She made an impact through her participation in national bodies. She managed to turn her teaching ideas/innovations into research outputs and the journey of her own evolusion is clear. She incorporated not only accounting skills in her teaching, but also critical cross-field outcomes.
She acted as a change agent in her department and conquered the resistance to change. She followed a reflective approach on her own personal journey and she made a concerted effort to understand student learning. She redesigned the taxation module to ensure that employer needs would still be met and that students would be enabled to think for themselves. She used innovative methods such as establishing a Facebook group, added additional tools for communication with students and used authentic examples. She communicated her expectations and the outcomes to students, and followed a whole brain approach. Development of the taxation curriculum was the main driver of educational change in the discipline. The innovation demonstrated lies in the incorporation of taxation content, different methods of assessment, podcasts for revision, the introduction of blended learning and practical sessions during which she applied her knowledge of behavioural psychology to students and colleagues. She managed to involve employers actively and adapted material and policies accordingly. This was a commendable project and Theresa Van Oordt is an impressive lecturer with huge potential.

Kgadi Mathabathe, Dr Darren Riley and Dr Lynne Pilcher
Project title: ‘Organic chemistry practicals: paradigm shift’
Kgadi Mathabathe is a lecturer in the Department of Science, Mathematics and Technology Education in the Faculty of Education. Dr Pilcher and Dr Riley are senior lecturers in the Department of Chemistry in the Faculty of Natural and Agricultural Sciences.
Kgadi Mathabathe completed the degree MSc in Chemistry Education at UP and was appointed as lecturer in 2010. She was awarded the prestigious Ros Moger/Terry Furlong Scholarship through the Canon Collins Trust towards her PhD. Dr Pilcher completed her PhD at Cambridge University, UK and did a postdoctoral fellowship at Brown University, USA. She joined UP in 2003 and was promoted to senior lecturer in 2007. Dr Riley completed his PhD and postdoctoral fellowship at WITS University, and joined iThemba Pharmaceuticals with an industrial placement at Cambridge University, UK. He was appointed at UP in 2013.
The third-year undergraduate practical course in organic chemistry had been purely recipe based until 2012. For the 2013 intake, the lecturers created an entirely new practical course, based on the enquiry approach. Two sessions were allocated to equipping individuals to work independently with a focus on developing the cognitive skills necessary for laboratory planning. The remaining four sessions were used for the “enquiry-based industrial project” in which students had to work in teams.
The enquiry-based industrial project was set in a simulated industrial context appropriate to the expectations of new graduates: teams of chemists were asked to assess experimentally three potential multi-step routes to prepare the product in terms of three key factors, namely cost, technical difficulty and environmental impact. Co-operative learning was structured using a jigsaw approach. Specialist teams had to develop a strategy for their synthetic route. This portion of the experiment represented guided enquiry . The project was planned in such a way that no one single route was the best in terms of all the stipulated criteria, thus the best route recommendation was open ended with results depending on experimentation and prioritisation of the criteria. The project not only equipped students with technical skills, but focused on areas such as development of metacognition and the establishment of a professional identity.
Contextualised enquiry based laboratory teaching afforded an improved quality of learning, made a difficult subject accessible and even popular and to some measure grew the students’ ability in all attributes desired in UP graduates.
Recent publications
Mathabathe, K C & Potgieter, M. 2014. ‘Metacognitive monitoring and learning gain in foundation chemistry’, Chemistry Education Research and Practice, 2014, 15: 94-104; Khazir, J, Mir, B A, Pilcher, L & Riley, D L. 2014. ‘Role of plants in anticancer drug discovery’, Phytochem Lett, 2014, 7: 173-181; Balogun, M O, Huws, E, Sirhan, M M, Saleh, A D, Al Dulayymi, J R, Pilcher, L, Verschoor, J A & Baird, M S. 2013. ‘Thiol modified mycolic acids’, Chemistry and Physics of Lipids, 2013, 172-173, 40-57.
Comments of the evaluators and moderator
The lecturers formed a very strong team, bringing different skills and competencies to the project and they used an enquiry-based approach, which is aligned with UP’s vision and the UP 2025 Strategy.
The introduction of an enquiry-based industrial project simulated the industry environment. Students had to establish a hypothetical company and follow a multi-step approach using cooperative learning groups. The lecturers introduced a metacognitive approach that forced students to think about their thinking. Reflective learning strategic questionnaires were used and critical cross-filed outcomes were incorporated in the projects. Students were assessed while doing a presentation at a mock board meeting. It became clear that there was a change in the students’ attitude and the number of honours students increased.
The innovative approach impacted on the Department of Chemistry, the Faculty and the discipline and it also influenced other disciplines. The lecturers did a presentation about the new practical course at a conference, and colleagues from 0other institutions showed interest. The most impressive impact of the project was the establishment of a professional identity among the students.

NRF-rated Researchers 2013/2014
NNS-gegradeerde Navorsers 2013/2014
Banyakišiši bao ba abetšwego maemo ke NRF 2013/2014

Prof Don Cowan
Prof Cowan is professor in the Department of Genetics in the Faculty of Natural and Agricultural Sciences. He serves as director of both the Genomics Research Institute and the Centre for Microbial Ecology and Genomics.
Most of Prof Cowan’s research activities are linked by the theme of environmental extremes. Researchers in his laboratory use microbiological, genomic, metagenomic and ecological techniques to investigate organisms living at high temperatures in deserts and hot pools, at very low temperatures in the dry valleys of the Antarctic and in a variety of other extreme environments. His work in the cold deserts of Antarctica made the greatest international impact. He and his researchers helped overturn a number of established paradigms and demonstrated that microbial populations in the Antarctic soils are much larger, more structurally and functionally diverse and more responsive to change than previously thought. His current studies in Antarctic microbiology have extended to the use of modern, functional metagenomics methods to identify and understand the molecular mechanisms that underpin the survival of microorganisms in one of the most extreme environments on earth. Prof Cowan collaborates with numerous laboratories and researchers from around the world, including South Africa, Namibia, Mozambique, Zimbabwe, Kenya, Zambia, Argentina, New Zealand, the UK, Germany and the USA. He holds the post of adjunct professor at the University of Waikato, New Zealand, was elected fellow of the Royal Society of South Africa in 2007, member of the Academy of Science for South Africa in 2008, and honorary fellow of the Royal Society of New Zealand in 2009. In 2008 he was awarded the Vice-Rector’s Award for Research Excellence at the University of the Western Cape and in 2009 he received the South African Society for Microbiology Silver Medal for Research Excellence. At present he is president of the Royal Society of South Africa and one of the South African national representatives on the Antarctic Treaty Scientific Committee for Antarctic Research (SCAR). He was awarded a NRF A2 rating in 2013. He is included in the Thompson’s ISI list of the world’s top 1% of researchers. Prof Cowan has published more than 40 research papers, review articles and book chapters, and sits on the editorial boards of ten international journals.
Prof Cowan is professor in die Departement Genetika in die Fakulteit Natuur- en Landbouwetenskappe. Hy dien as direkteur van sowel die Genomika-navorsingsinstituut en die Sentrum vir Mikrobiese Ekologie en Genomika.
Die meeste van prof Cowan se navorsingsaktiwiteite het te doen met ekstreme omgewingstoestande. Navorsers in sy laboratorium gebruik mikrobiologiese, genomiese, metagenomiese en ekologiese tegnieke om organismes wat by hoë temperature in woestyne en warmwaterpoele, by uiters lae temperature in die droë Antarktiese vallei en ʼn verskeidenheid van ander ekstreme omgewings lewe. Sy werk in die ysige woestyne van Antarktika het die grootste internasionale impak gehad: hy en sy navorsers het gehelp om ʼn hele aantal gevestigde paradigmas om te keer en het bewys dat die mikrobiese populasies in die grond van Antarktika baie groter en struktureel en funksioneel meer divers is en beter reageer op verandering as wat vroeër gereken is. Sy huidige navorsing oor Antarktiese mikrobiologie sluit ook die gebruik van moderne, funksionele metagenomika-metodes in om die molekulêre meganismes te identifiseer en te verstaan wat die oorlewing van mikroörganismes in een van die mees ekstreme omgewings ter aarde onderlê. Prof Cowan werk saam met talle laboratoriums en navorsers van oor die hele wêreld, insluitend Suid-Afrika, Namibië, Mosambiek, Zimbabwe, Kenia, Zambië, Argentinië, Nieu Seeland, die VK, Duitsland en die VSA. Hy is ʼn adjunkprofessor aan die Universiteit van Waikato, Nieu Seeland en is in 2007 verkies as lid van die Koninklike Vereniging van Suid-Afrika, in 2008 as lid van die SuidAfrikaanse Akademie vir Wetenskap (ASSAf) en in 2009 as lid van die Koninklike Vereniging van Nieu-Seeland. Hy het in 2008 die Viserektor se Toekenning vir Uitnemendheid van die Universiteit van die Wes-Kaap ontvang en in 2009 die SuidAfrikaanse Vereniging vir Mikrobiologie se Silwer Medalje vir Uitnemendheid in Navorsing. Prof Cowan is die huidige president van die Koninklike Vereniging van Suid-Afrika en een van Suid-Afrika se nasionale verteenwoordigers in die Antarctic Treaty Scientific Committee for Antarctic Research (SCAR). Die NNS het ’n A2-gradering in 2013 aan hom toegeken en hy verskyn op Thompson se ISI-lys van die top 1% van navorsers wêreldwyd. Prof Cowan het reeds meer as 40 navorsingsartikels, oorsigartikels en hoofstukke in boeke gepubliseer en dien op die redaksionele rade van tien internasionale vaktydskrifte.
Prof Cowan ke profesa ka Kgorong ya Leabela mo Lefapheng la Disaense tša Tlhago le Temo. Ke molaodimogolo wa Institute ya Nyakišišo ya Tšenomiki le Senthara ya Ekholotši ya Maekrobayale.
Mešongwane ye mentši ya nyakišišo e kopantšwe ke tabakgolo ya dipheteletšo tša tikologo. Banyakišiši laporatoring ya gagwe ba šomiša maekropayolotši, tšenomiki, matetšenomiki le dithekniki tša ekholotši go nyakišiša diphedi tše di phelago dithemperetšheng tša godimo maganateng le megobeng ya go fiša, ka thempheretšha ya fase mo meeding ya Antarctic le mehuta ya ditikologo tše di feteleditšwego. Mošomo wa gagwe maganateng a go tonya a Antarctica o bile le seabe se se golo sa ditšhabatšhaba. Yena le banyakišiši ba gagwe ba thušitše go fetola mehlala ye mmalwa yeo e utollotšwego gomme ba laetša dipehdi tša maekropaele mo mabung a Antarctic ke ye kgolo kudu, ka mehuta ya sebopego le ka go šoma gomme e arabela go diphetogo go feta ka moo go bego go gopolwa ka gona mathomong. Dinyakišišo tša gagwe tša bjale ka maekropayolotši wa Antarctic di okeditšwe go šomiša mekgwa ya sebjale ya go šoma ga dimetagenomiki go lemoga le go kwešiša didirišwa tša molekhula tšeo di thekgago phologo ya diphidinyana go ye nngwe ya ditikologo tše šoro kudu mo Lefaseng.
Prof Cowan o šomišana le dilaporatori le banyakišiši ba bantši lefaseng ka moka, go akeretšwa Afrika Borwa, Namibia, Mozambique, Zimbabwe, Kenya, Zambia, Argentina, New Zealand, UK, Germany le USA. Ke mothuša profesa Yunibesithing ya Waikato, New Zealand, o kgethilwe bjalo ka modirišane wa Mokgatlo wa Bogoši wa Afrika Borwa ka 2007, leloko la Akademi ya Saense Afrika Borwa ka 2008, modirišana wa tlhompho wa Mokgatlo wa Bogoši wa New Zealand ka 2009. Ka 2008 0 abetšwe Sefoka sa Motlatšahlogo sa Nyakišišo ya Bokgoni Yunibesithing ya Western Cape gomme ka 2009 o amogetše Metale wa Silibere wa Maekropayolotši wa Nyakišišo ya Bokgoni wa Mokgatlo wa Afrika Borwa. Ga bjale ke presidente ya Mokgatlo wa Bogoši wa Afrika Borwa gomme ke yo mongwe wa baemedi ba gae ba Afrika Borwa mo Komiting ya Saense ya Tumelelano ya Antarctic ya Nyakišišo ya Antarctic (Antarctic Treaty Scientific Committee for Antarctic Research (SCAR)). O abetšwe tekanyo ya NRF ya A2 ka 2013. O akareditšwe lenaneong la Thompson’s ISI la lefase la banyakišiši ba godimo ba 1%. Prof Cowan o phatladitše dimpapiri tša dinyakišišo tša go feta tše 40, o lekotše diathekele le dikgaolo tša dipu ku, gomme o thuša makgotleng a barulaganyi a ditšenale tše lesome tša ditšhabatšhaba.

Prof Brenda Wingfield
Prof Wingfield is deputy dean responsible for research in the Faculty of Natural and Agricultural Sciences. Her research interests include population genetics, phylogenetics and genomics of fungi. Her research team was the first to sequence a fungal genome in Africa – that of the important pine pathogen, Fusarium circinatum. This fungus is one of many that her research group is studying at genome level.
Prof Wingfield has been the supervisor or co-supervisor of 41 master ’s students and 44 PhD students. She is currently the supervisor or co-supervisor of six MSc students and six PhD students. She has published more than 300 peer-reviewed articles and has an ISI h index of 35.
She serves on the council of the Academy of Science of South Africa and on the editorial boards of Current Genetics and the journal of the British Mycology Society, Fungal Biology. She is a former chairperson of the National Science and Technology Forum and a project leader in the Department of Science and Technology (DST)/NRF Centre of Excellence in Tree Health Biotechnology.
She was the winner of the Department of Water Affairs and Forestry’s Women in Water, Sanitation and Forestry Research Award in 2007, the Department of Science and Technology (DST) Women in Science Award in 2008 and the African Union’s Women in Science Regional (Southern) Award in 2009.
Prof Wingfield is an A2 rated NRF researcher.
Prof Wingfield is adjunk-dekaan verantwoordelik vir navorsing van die Fakulteit Natuur- en Landbouwetenskappe. Haar navorsingsbelangstellings sluit bevolkingsgenetika, filogenetika en die genomika van swamme in. Haar navorsingspan was die eerste in Afrika om die volgorde van ʼn swamgenoom – die van Fusarium circinatum, die belangrike patogeen in dennebome – te bepaal. Hierdie swam is een van vele wat deur haar navorsingsgroep op genoomvlak bestudeer word.
Prof Wingfield het reeds as studieleier of medestudieleier vir 41 meesters- en 44 PhD-studente opgetree. Sy is tans studieleier of medestudieleier van ses MSc- en ses PhD-studente. Sy het reeds meer as 300 portuurbeoordeelde artikels gepubliseer en het ʼn ISI h-indeks van 35.
Sy dien in die raad van die Suid-Afrikaanse Akademie vir Wetenskap en in die redaksionele rade van Current Genetics, asook die British Mycology Society se vaktydskrif, Fungal Biology. Sy is voormalige voorsitter van die nasionale Forum vir Wetenskap en Tegnologie en ʼn projekleier in die Sentrum vir Uitnemendheid in Boomgesondheidsbiotegnologie van die Departement van Wetenskap en Tegnologie (DWT) en die Nasionale Navorsingstigting.
In 2007 het sy die Departement Waterwese en Bosbou se Vroue in Water, Sanitasie en Bosbou Navorsingstoekennning, in 2008 die Departement van Wetenskap en Tegnologie (DWT) se Vroue in Wetenskap Toekenning en in 2009 die Afrika-Unie se Vroue in Wetenskap Streekstoekenning (Suid) ontvang.
Prof Wingfield is ʼn A2-gegrageerde navorser van die NNS.
Prof Wingfield ke motlatšahlogo wa Lefapha la Disaense tša Tlhago le Temo. Kgahlego ya gagwe ya nyakišišo e akaretša leabela la batho, leabela la mehlobo le tšenomiki ya mouta. Sehlopha sa gagwe sa nyakišišo ke sa mathomo go latelantšha ditšenome tša mouta ka Afrika – ya bohlokwa bja pathotšene ya phaene, Fusarium circinatum. Mouta wo ke wo mongwe ya ye mentši ya yeo sehlopha sa gagwe sa nyakišišo se ithutago ka sona legatong la tšenome.
Prof Wingfield e bile molekodi wa baithutu ba 41 ba mastase le ba 44 ba PhD. Ga bjale ke molekodi wa baithuti ba tshela ba MSc le ba tshela ba PhD. O phatlaladitše diathekele tšeo di lekotšwego ke badirišane tša go feta 300 gomme o na le tšhupane ya ISI ya 35.
O thuša mo khanseleng ya Akademi ya Saense ya Afrika Borwa le lekgotleng la barulaganyi ba Current Genetics le tšenale ya Lekgotla la Maekholotši la Britian, Fungal Biology. Ke modulasetulo wa pele wa Foramo ya Setšhaba ya Saense le Theknolotši gomme ke moetapele wa protšeke Kgorong ya Saense le Theknolotši (DST)/Senthara ya Bokgoni ya Payotheknotši ya Maphelo a Mehlare ya NRF.
E bile mothopasefoka wa Sefoka sa Nyakišišo ya Basadi Meetseng, Tlhwekišo le Kagodikgwa sa Kgoro ya Mereo ya Meetse le Kagodikgwa ka 2007, Sefoka sa Kgoro ya Saense le Theknolotši sa Basadi Theknolotšing ka 2008 le Sefoka sa Kopano ya Afrika sa Selete sa (Borwa) sa Basadi le Saense ka 2009.
Prof Wingfield o lekanyeditšwe ke NRF bjalo ka monyakišiši wa A2.



Dr Kai-Ying (Alice) Chan
Prof Bittencourt is associate professor in the Department of Economics in the Faculty of Economic and Management Sciences. Prof Bittencourt holds a PhD from the University of Bristol in the United Kingdom, and is affiliated with the universities of Göttingen and Heidelberg in Germany.
His broad research interests are political economy, economic growth, development macroeconomics and public economics. More specifically, he works on the political causes and economic consequences of hyper-inflationary episodes, the economic and political determinants of inequality, the role of financial development on growth, the role of political regime characteristics on government size and macroeconomic performance in general, the effect of economic activity on government debt, and the determinants and consequences of democracy. He has presented papers at conferences such as the annual meetings of the Royal Economic Society and the European Economic Association. His papers have appeared in journals such as Developing Economies, Economic Change and Restructuring, Economic Modelling, Journal of Policy Modelling and Economics of Governance. Prof Bittencourt received a C2 rating from the NRF.
Prof Broere is professor in the Department of Mathematics and Applied Mathematics in the Faculty of Natural and Agricultural Sciences. His area of research is graph theory, a specialisation area of combinatorics. In the last five years his most important contributions have been in the area of specialisation known as Hereditarnia (see http://hereditarnia.ics.upjs.sk/) and more specifically, related to the existence and constructions of universal graphs for and in hereditary properties of graphs. Prof Broere received a C1 rating from the NRF.
Dr Chan is a senior lecturer in the Graduate School of Technology Management in the Faculty of Engineering, Built Environment and Information Technology. Her research is focused mainly on theory-based empirical studies of knowledge networks and innovative behaviour of organisations. Other research topics include science parks, project teams, innovative performance and technology acquisition modes. Dr Chan’s most significant recent publication was an article titled ‘Knowledge exchange behaviours of science park firms: the innovation hub case’, which was published in Technology Analysis & Strategic Management in 2010. Dr Chan received a Y2 rating from the NRF.
Prof Chetty is professor in the Department of Physics in the Faculty of Natural and Agricultural Sciences. He uses theoretical techniques based on quantum mechanical modelling to study real material systems. Current interests include studies of graphene, which is the first truly two-dimensional material and was first synthesised less than a decade ago. Prof Chetty’s primary focus is the band-gap engineering of this material and its iso-structural counterpart, boronitrene, by doping these systems with various defects and adatoms. He has developed his own computational codes based on density functional methods. He is licenced to use the Vienna ab initio simulation package (VASP), as well as the Quantum-ESPRESSO codes.
Prof Chetty’s research group is a prolific user of the faculty’s recently upgraded computational cluster, and he also uses the computational resources at the Centre for High Performance Computing in Cape Town. He received the American Fulbright Fellowship twice (in 1985 and 2004) and the NRF President’s Award in 1997. He is currently partially seconded to the NRF as Group Executive for Astronomy where he is responsible for managing South Africa’s national interests in astronomy. He has supervised eight doctoral students. Prof Chetty received a C2 rating from the NRF.
Dr Cleophas is research fellow in the Department of Computer Science in the Faculty of Engineering, Built Environment and Information Technology. His main research interests are algorithms and automata for text and tree-structured data processing, model driven engineering (MDE), code generation, software language engineering, and software correctness-by-construction. He is currently conducting fundamental and applied research on finite automata algorithms, domain specific languages and MDE techniques.
Dr Cleophas obtained a PhD in Computer Science and Engineering from Eindhoven University of Technology in the Netherlands in 2008. He subsequently worked in academia and industry, on topics ranging from text processing algorithmics to MDE. He spent 2009 at the University of Pretoria as a postdoctoral fellow with bursaries from both UP’s Postdoctoral Fellowship Programme and the NRF’s prestigious Freestanding Postdoctoral Fellowship Programme. He has contributed to highperformance software in areas as diverse as web image gallery searches and lithography machine hardware simulation. Dr Cleophas has authored or co-authored more than 30 articles and chapters in refereed journals, conference proceedings and books. He is a member of the Association for Computing Machinery, the Institute of Electrical and Electronics Engineers Computer Society and the South African Institute for Computer Scientists and Information Technologists. Dr Cleophas received a Y2 rating from the NRF.
Prof Dreyer is head of the Department of Practical Theology. Her current research centres on a project entitled ‘Gender, power, sexuality and pastoral engagement’. Project themes include the question whether the Bible is good news for human sexuality, ‘de-centre-ing’ sexual difference, the ‘sanctity’ of marriage and its mythological origins, forms and models, prejudice and homophobia, heteronormativity as a root of hegemony and internalised homophobia, and an inclusive pastoral theological perspective on marginalisation and difference. Other research foci include ‘sola Scriptura – a unifying or divisive factor?’ and pastoral psychology. Prof Dreyer was invited to present the inaugural Robert Berkey Lecture at Otterbein University in Westerville, Ohio in May 2011 and delivered a keynote address at the International Academy for Practical Theology in Amsterdam the following month. She is the author of a monograph on institutionalisation and Jesus published in 2012 in the USA. Since last year she has been, by invitation, part of the research project entitled ‘New directions in practical theology’ at Princeton Theological Seminary. Prof Dreyer has been a member of the Global Network of Theologians advising the World Communion of Reformed Churches since 2011. She received the HCM Fourie Award for her Contribution to Reformational Theology from the Netherdutch Reformed Church of Africa (Nederduitsch Hervormde Kerk van Afrika) in 2013. She received a C2 rating from the NRF.






Prof Duncan is professor and head of the Department of Church History and Church Polity in the Faculty of Theology. His field of research is South African mission history from an ecumenical perspective with a particular focus on mission education, theological education and the history of Presbyterianism. He is the co-author of The native school that caused all the trouble: A history of the Federal Theological Seminary in Southern Africa (Pietermaritzburg: Cluster, 2011) of which it has been said that ‘[it] will undoubtedly become the definitive study on Fedsems’ (Prof John de Gruchy, Robert Selby Taylor Professor of Christian Studies, University of Cape Town). The book focuses on the development of the finest experiment in ecumenism in the history of Christianity in South Africa. He is currently working on a history of the Bantu/Reformed Presbyterian Church in Southern Africa (1923–1999), the product of the mission of the United Free Church of Scotland. Prof Duncan received a C3 rating from the NRF.
Dr Elwen is a research fellow at the Mammal Research Institute, where he previously completed his MSc and PhD. A comprehensive review of all published data on cetaceans in southern Africa, led by Dr Elwen and colleagues, highlighted the lack of basic information available on most species of marine mammal fauna including population size, stock structure and conservation status. Much of Dr Elwen’s research aims to fill in some of the gaps in the baseline data for cetacean populations in Namibia and South Africa.
Dr Elwen currently leads the Namibian Dolphin Project (NDP), based in Walvis Bay, where he spends most of his time. The NDP tackles a broad range of ecological and behavioural questions on cetacean biology, ranging from dolphin communication to population assessments. Much of the NDP and Dr Elwen’s work focuses on the interaction of cetaceans with human activities such as coastal development and tourism, as well as the behavioural adaptations of cetacean top predators to different environmental conditions. Dr Elwen’s research group has made several exciting observations in Namibia such as the first sighting of a grey whale in the southern hemisphere. The group has pioneered the use of Passive Acoustic Monitoring (PAM) techniques to monitor cetaceans in Namibia and South Africa. Dr Elwen received a Y2 rating from the NRF.
Prof Ferreira is associate professor and head of the Department of Educational Psychology in the Faculty of Education. She is theme leader in the Institute for Food, Nutrition and Well-being (IFNuW) where interdisciplinary research is conducted on behavioural change towards health and well-being.
Her research interests include psychosocial support in the context of vulnerability, asset-based psychosocial coping and resilience, using participatory action research in combination with intervention-based studies to improve community-based coping, and the health and well-being of resource-constrained communities.
In 2012 she was visiting professor at Fordham University (USA) and Providence College, Rhode Island (USA). In the same year, a longitudinal research project that had been on-going since 2003 resulted in the publication, Partnering for Resilience, co-authored by L Ebersöhn and published by Van Schaik.
In recognition of her research accomplishments Prof Ferreira has been the recipient of several awards, including the Samuel Henry Prince Dissertation Award of the International Sociological Association (2009), the Young Researcher Award of the University of Pretoria (2009) and the Young Researcher Award of the Education Association of South Africa (2007). Prof Ferreira received a C3 rating from the NRF.
Dr Findlay is the director of the Mammal Research Institute’s Whale Unit in the Department of Zoology and Entomology. The unit, based in Cape Town, researches the ecology, population dynamics and behaviour of cetaceans (whales, dolphins and porpoises) in southern African waters, with the principal objective of providing knowledge that will promote their conservation.
Dr Findlay is a marine mammal biologist with over 20 years of research and consulting experience in southern Africa. He has considerable field experience across a broad geographic range, having led and participated in whale and dugong research in the Southern Ocean, the Western Indian Ocean, the Arabian Sea, the Eastern Pacific Ocean and in the southern African environment, particularly Mozambique. Dr Findlay received a C3 rating from the NRF.
He has been an invited member of the International Whaling Commission’s Scientific Committee since 1997 and currently sits on the Southern Ocean Research Partnership’s Acoustic Steering Committee. He is an invited member of the International Union for the Conservation of Nature’s Cetacean Specialist Group, and a member of the Marine Mammal Society and the Western Indian Ocean Marine Science Association. His research interests include the population status of marine mammal populations and Southern Ocean marine mammal ecology.
Prof Fioramonti is associate professor in the Department of Political Sciences and director of the Centre for the Study of Governance Innovation (GovInn). He is a senior fellow of the Centre for Social Investment, University of Heidelberg, Germany and the Hertie School of Governance, also in Germany, and associate fellow of the United Nations University. Prof Fioramonti is the first and only holder of the Jean Monnet Chair in Africa, a prestigious recognition awarded by the European Commission to distinguished academics in the field of regional integration studies. In 2012, Prof Fioramonti received the UP Exceptional Young Researcher Award and in 2014 he was nominated as UNESCO-UNU Chair in Regional Integration, Migration and Free Movement of People. Prof Fioramonti received a C2 rating from the NRF. His research interests range from comparative regionalism to EU studies, civil society, the governance of the commons and alternative political economies.
His recent publications include: Civil society and world regions (Lexington, 2014); How numbers rule the world: the use and abuse of statistics in global politics (Zed Books, 2014); Citizens vs. markets: how civil society is rethinking the economy in times of crisis (Routledge, 2013); Gross domestic problem: the politics behind the world’s most powerful number (Zed Books, 2013).


Dr Forbes is a senior lecturer in the Department of Chemistry in the Faculty of Natural and Agricultural Sciences. Her research focuses primarily on atmospheric analyses involving the development of novel sampling and analytical methods for environmental pollutants of relevance to South Africa, including polycyclic aromatic hydrocarbons and pesticides. Dr Forbes’ other research interests include analytical chemistry education, specifically in enhancing students’ understanding of spectroscopy. To this end she has developed an educational spectrophotometer, the SpecUP, which has been implemented in a number of university programmes throughout Africa.
Dr Forbes has served on the organising and scientific committees of numerous local and international conferences and has published more than ten peer-reviewed journal papers and more than twenty-five conference presentations over the last five years. A number of her postgraduate students have won awards for their presentations at these conferences. Dr Forbes serves on the Executive of the South African Chemical Institute and chairs the Chromatography Division of the Institute. Dr Forbes received a Y2 rating from the NRF.


Dr Bernard Fourie


Dr Fourie is extraordinary professor in the Department of Medical Microbiology in the Faculty of Health Sciences, where he leads several large-scale projects in tuberculosis (TB), mostly with international collaboration and funding. His scientific contributions to peer reviewed scientific journals and textbooks number more than 100 and he regularly participates as invited and keynote speaker in international and national conferences on TB. Currently, Dr Fourie is making novel contributions to the field of inhaled therapies for tuberculosis, in particular pulmonary delivery of drugs and vaccines. He is also pursuing novel approaches to the simplification of molecular-based testing for tuberculosis, and is engaged in international efforts towards advanced drug resistance profiling of TB by next generation, whole genome sequencing. Dr Fourie received a C2 rating from the NRF.
His recent publications include: Daum, L T, Fourie, P B, Bhattacharya, S, Ismail, N A, Gradus, S, Maningi, NE & Fischer, G. 2014. ‘Next-generation sequencing for identifying pyrazinamide resistance in Mycobacterium tuberculosis’, Clinical Infectious Diseases, Epub; Dhillon, J, Fourie, P B & Mitchison, D A. 2014. ‘Persister populations of Mycobacterium tuberculosis in sputum that grow in liquid but not on solid culture media’, Journal of Antimicrobial Chemotherapy, 69(2): 437c440; Hickey, A J, Misra, A & Fourie, P B. 2013. ‘Dry powder antibiotic aerosol product development: inhaled therapy for tuberculosis’, Journal of Pharmaceutical Sciences, 102(11): 3900–3907.
Dr Garnas is a senior lecturer in the Department of Zoology and Entomology, in the Faculty of Natural and Agricultural Sciences and a member of the management team of the Forestry and Agricultural Biotechnology Institute. His research focuses on understanding the population dynamics, community and evolutionary ecology of organisms associated with forest trees. Specific interests include how ecological and evolutionary processes and interactions with tree defences and microbes drive host use and community structure in insects. Dr Garnas has authored or co-authored 15 articles in peer-reviewed journals, including papers in the Journal of Ecology, Ecography and Biology Letters. Dr Garnas received a Y2 rating from the NRF.
Prof Gaspar is associate professor in the Department of Biochemistry in the Faculty of Natural and Agricultural Sciences. She leads the Biotherapeutics Research Group and her research focus is the biochemical characterisation of tick proteins or peptides with therapeutic potential. Most of her work has been on anti-haemostatics, but currently in search of novel antibiotics, her group is investigating the antimicrobial properties of shorter peptides based on a tick defensin. Besides their antimicrobial role, derived peptides exhibit anti-endotoxin, anti-oxidant and nitric oxide scavenging activity. Multifunctional peptides may have further potential applications, for example in wound healing and as anti-sepsis agents. Peptides present in an indigenous beverage exhibiting anti-hypertensive properties are also being investigated.
To date Prof Gaspar has supervised twelve MSc and three PhD students and she is currently supervising four MSc and three PhD students. She has published 17 articles in peer-reviewed international journals, and her research has been presented at numerous local and international conferences. She has served as council member of the South African Society of Biochemistry and Molecular Biology, has reviewed manuscripts for several reputable journals and is currently on the editorial advisory board of the Brazilian Journal of Veterinary Parasitology. Prof Gaspar received a C3 rating from the NRF.
Prof Gelderblom is associate professor in the Department of Informatics in the Faculty of Engineering, Built Environment and Information Technology. She works mainly in the field of human-computer interaction (HCI) with emphasis on the design of technology for special user groups such as children, the elderly and computer illiterate persons. She has a special interest in the evaluation of mobile and computer interfaces through eye tracking and in the application of technology in education. Before joining UP in November 2013, she was associate professor in the School of Computing at the University of South Africa (Unisa) where she led the HCI research group and managed the school’s HCI laboratory. In 2011 she received a Fulbright scholarship that allowed her to work at the prestigious HCI lab of the University of Maryland. In the same year she received Unisa’s ‘Women in research: Leadership Award’. Prof Gelderblom’s recent publications have focused on the use of technology in computer science education and co-designing technology with children. Prof Gelderblom received a C3 rating from the NRF.

Prof Groenewald is associate professor in the Department of Old Testament Studies in the Faculty of Theology. The main focus of his research is the book of Isaiah (chapters 1–12). The textual analysis seriously considers the historical embeddedness of the text of the book of Isaiah as it is the product of a long and complicated process of transmission. It is rooted in the concreteness of human history and cannot be properly understood apart from that historical rootedness.
Prof Groenewald retains both synchronic and diachronic analysis of the text because a synchronic analysis indicates a developmental history of Isaiah 1–12 in different layers. Although the chapters are presented as a single block of literature, detailed analysis demonstrates that it is a composite work written over the course of several centuries. The many interrelationships between the various parts of the book of Isaiah indicate successive re-readings of the Isaianic tradition in the light of later historical circumstances. A key focus of Prof Groenewald’s exegesis is the exploration of the ways in which these texts link with other texts within the canon, specifically with texts in the Pentateuch. He received a C2 rating from the NRF
Recent articles by Prof Groenewald include:
‘The Significance of תורה (Isa 2:3) within Isaiah 2:1–5: the relationship of the first overture (1:1–2:5) to the book’s conclusion (Isa 65–66)’, Old Testament Essays, 26(3), 695–717 (2013); ‘Isaiah 1:2−3 and Isaiah 6: Isaiah “a prophet like Moses” (Dt 18:18)’, HTS Teologiese Studies / Theological Studies, 68(1), art. #1311, 7 pages. http://dx.doi.org/10.4102/ hts.v68i1.1311 (2012); ‘Isaiah 1:2−3, ethics and wisdom. Isaiah 1:2–3 and the Song of Moses (Dt 32): Is Isaiah a prophet like Moses?’, HTS Teologiese Studies / Theological Studies, 67(1), art. #954, 6 pp. DOI: 10.4102/hts. v67i1.954 (2011).
Prof Hancke is emeritus professor in the Department of Electrical, Electronic and Computer Engineering in the Faculty of Engineering, Built Environment and Information Technology, as well as programme coordinator for Computer Engineering. He heads the Group for Advanced Sensor Networks (GSN) and enjoys international recognition for his work in GSN, especially with regard to industrial applications. Prof Hancke was guest editor of the first special edition on industrial GSN in IEEE Transactions on Industrial Electronics (2009). In the same edition he co-authored an article that has since been cited about 400 times. He was co-editor of the first textbook on industrial GSN, which appeared in 2013. He collaborates and publishes with researchers from all over the world. In South Africa he was awarded the Department of Trade and Industry’s THRIP Technology Award in the Small, Medium and Micro Enterprises Development Category (2007) and in the Category for Advanced Technology (2011). Internationally he has served as chair of committees and on the board of directors of the Institute of Electrical and Electronics Engineers (IEEE) and the Industrial Electronics Society for the past 15 years. He is known for organising high level conferences and was a recipient of the IEEE Larry K Wilson International Award. Prof Hancke received a B2 grading from the NRF.



Prof Human-Vogel is associate professor in the Department of Educational Psychology in the Faculty of Education.
As a registered educational psychologist, she trains honours and MEd (Educational Psychology) students in family-oriented intervention. She is recognised for her research on positive self-regulation, and the antecedents and consequences of commitment in academic and interpersonal contexts. Commitment is fundamental to most notable human achievements, and Prof Human-Vogel is interested in understanding how identity can shape and strengthen people’s commitments and provide a framework for the attainment of future goals.
Several masters and PhD students have completed their studies under her supervision. Her research is published regularly in national and international journals. Her most recent publication is a book chapter on well-being research in South Africa in an international series on cross-cultural advancements in positive psychology. Prof Human-Vogel received a C3 rating from the NRF.


Prof Kok is associate professor in the Department of New Testament Studies in the Faculty of Theology. His research focuses on the dynamic relationship between mission and ethics in the New Testament and early Christianity, the construction of early Christian identity, the drawing and transcendence of social boundaries in times of conflict and change, and the dimension of ‘healing’, restoration and reconciliation in early Christianity. Prof Kok is also one of only a few New Testament scholars in the world who uses the Dialogical Self Theory as heuristic tool for New Testament interpretation.
Prof Kok serves on the steering committee of the Healthcare and Disability in the Ancient Near East Section of the International Society of Biblical Literature. His research on healing, restoration and reconciliation in John will be published in 2014 by Brill (Leiden and New York). His work on mission and ethics has resulted in a comprehensive reference volume, Sensitivity to outsiders, co-edited by Tobias Nicklas, Dieter T Roth and Christopher M Hays and published by Mohr Siebeck in Tübingen. Together with John A Dunne from St Andrews, he has edited Insiders versus outsiders, a monograph that will be published by Gorgias Press in Piscataway, USA. Prof Kok received a Y1 rating from the NRF.
Dr Lenhardt is a lecturer in the Department of Geology in the Faculty of Natural and Agricultural Sciences. His current research focuses on ancient to recent volcanism on the African continent with projects in Sudan (Bayuda monogenetic volcanic field), Tanzania (Ngozi caldera, Rungwe volcanic province), Cameroon (Mount Cameroon) and South Africa (the Precambrian volcanic rocks of the Ventersdorp Supergroup, the Pretoria Group and the Rooiberg Group). From the Archaean to the present, all of Africa’s volcanoes are related to either hotspots, rifting or a combination of the two, and are primarily characterised by fissure vents (shield volcanoes) and pyroclastic cones (stratovolcanoes). It is therefore not unusual that many African volcanoes from the Archaean to the present show similar features and can be related to similar formational processes. The aim of Dr Lenhardt’s research is to define and detail this connection between ancient and modern volcanism in Africa and to find possible parameters that may have changed over time. Other research areas of interest include economic geology, particularly the oil and gas reservoirs of Sudan and the South African Karoo.
During the last four years of Dr Lenhardt’s research, he has published 12 journal articles and two chapters in monographs. Dr Lenhardt received a Y2 rating from the NRF.
Dr Lindsey is an honorary lecturer at the Mammal Research Institute in the Department of Zoology and Entomology, Faculty of Natural and Agricultural Sciences. He is an applied conservation biologist who works throughout southern Africa on a wide variety of issues that affect the persistence of wildlife, both inside and outside protected areas. Recent publications have touched on conservation policy, wildlifebased land uses, the bushmeat trade, human-wildlife conflict, predator conservation, protected area management and the role of fencing. Dr Lindsey has published (or has in press) 25 primary author and 12 secondary author papers. Increasingly, he strives to ensure that his work is presented to decision-makers in the region.
Dr Lindsey received a C2 rating from the NRF.
Prof Malan is professor in Public Law in the Faculty of Law. He focuses and publishes on critical theory of constitutional law which subsumes a critique of legal scholarship dictated by the statist paradigm, the phenomenon of constitutional change, constitutional supremacy, sovereignty of the law, democracy, the extent to which the territorial state is equipped and able to cope with legitimate minority claims and language law.
His most important publications of the last five years include an academic monograph, Politokrasie: ‘n peiling van die dwanglogika van die territoriale staat en gedagtes vir ’n antwoord daarop, published by Pretoria University Law Press (PULP) in 2011. In 2012, PULP published the title in English as Politocracy: an assessment of the coercive logic of the territorial state and ideas around a response to it. In the same period, Prof Malan also authored two comprehensive articles, namely ‘Observations on representivity, democracy and homogenisation’, published in Tydskrif vir die Suid-Afrikaanse Reg / Journal of South African Law, 2010(3): 427–449 and ‘The rule of law versus decisionism in South African constitutional discourse’, published in De Jure, 2012(45): 272–305.
Prof Malan received a C2 grading from the NRF.
Prof Meiring is associate professor in the Department of Human Resource Management in the Faculty of Economic and Management Sciences. His research examines industrial psychology and cross-cultural psychology in the workplace with the focus on personnel psychology and assessment practice in multicultural settings, including workplace personality measurement, cross-cultural assessment, personnel selection and applied cross-cultural methodology. He is involved in a major research project, the South African Personality Inventory Project, which focuses on the development of an indigenous personality inventory for the 11 language groups in South Africa.
In 2008 Prof Meiring established the Assessment Centre Research Focus Area at the Assessment Centre Study Group (ACSG). The research produced in this focus area is aimed at developing a research centre of excellence in the study of assessment centres and their applied value in the South African context. In 2010 Prof Meiring was made honorary member of the ACSG in recognition of his research on assessment centres in South Africa. In 2013 he established a behaviour laboratory in the Department of Human Resource Management where current research focuses on the physiological impact of sample-based selection procedures on candidates in an assessment centre. Prof Meiring received a C3 rating from the NRF.




Dr Leith Meyer

Dr Meyer is a senior lecturer in Veterinary Pharmacology in the Department of Paraclinical Sciences in the Faculty of Veterinary Science at the University of Pretoria. His areas of research include wildlife pharmacology, anaesthesiology and medicine, conservation physiology and drug development. Dr Meyer received the NRF Thuthuka Researchers-in-Training Grant for the period 2006 to 2011, the 2011 Innovation Fund Award for a blood pressure monitor patent and the NRF Thuthuka Post-PhD Track Grant for 2012 to 2014. Dr Meyer received a Y2 rating from the NRF.
Recent publications include: Hetem, R S, Mitchell, D, De Witt, B A, Fick, L G, Meyer, L C R, Maloney, S K, & Fuller, A. 2013. ‘Cheetah do not abandon hunts because they overheat’, Biology Letters, 9(5): 20130472; Meyer, L C R, Fuller, A & Mitchell, D. 2006. ‘Zacopride and 8-OH-DPAT reverse opioid-induced respiratory depression and hypoxia but not catatonic immobilization in goats’, American Journal of Physiology: Regulatory, Integrative and Comparative Physiology, 290: R405–R413; Meyer, L et al. 2008. ‘Hyperthermia in captured impala (Aepyceros melampus): a fright not flight response’, Journal of Wildlife Diseases, 44(2): 404–416.
Prof Meylahn is associate professor in the Department of Practical Theology in the Faculty of Theology. His research over the past years can be described as a conversation among philosophy, philosophy of religion and practical theology. The focus of the research is the implication of this interdisciplinary conversation for practical/public theology. The focus can be divided into three key areas: firstly, theory and methodology of practical theology in conversation with insights from the linguistic turn in philosophy; secondly, practical theological challenges to philosophy of religion after the linguistic turn; and thirdly, the implication of this conversation specifically for congregational studies and pastoral care. Prof Meylahn received a C2 rating from the NRF.
Important publications by Prof Meylahn include two monographs and a chapter in conference proceedings:
‘The limits and possibilities of postmetaphysical God-talk: a conversation between Heidegger, Levinas and Derrida’, Studies in Philosophical Theology, 52, Leuven: Peeters; The Church emerging from the cracks: a church in, but not of the world. Bloemfontein: SUN MeDIA; ‘Celebrating the neuroscientific body sacramentally: reading the body as sacrament – a radical incarnational theo-logos’, in P Jonkers & M Sarot (eds), Embodied religion: Proceedings of the 2012 Conference of the European Society for Philosophy of Religion, Ars Disputandi, Supplement Series 6, Utrecht, pp. 251–264.

Dr Moleleki is a senior lecturer in the Department of Microbiology and Plant Pathology in the Faculty of Natural and Agricultural Sciences at the University of Pretoria, a research group leader at the Forestry, Agricultural and Biotechnology Institute and the leader of the Bacterial Genomics and Host Pathogen Interactions Research Group.
Dr Moleleki obtained a PhD at the Scottish Crop Research Institute (now The James Hutton Research Institute) at Dundee University, United Kingdom investigating molecular interactions between soft rot pathogens and potato plants. Upon her return to South Africa, she established a research group at the University of Pretoria focusing on potato pests and pathogens in South Africa. Her most significant research outputs to date include co-authoring an article in Nature publication in and one in Annual Review of Phytopathology in 2012. Dr Moleleki received a Y2 rating from the NRF.
Prof Naraidoo is associate professor of Economics in the Faculty of Economic and Management Sciences. Before joining the University of Pretoria he held lectureships at Keele University, UK and the University of Nottingham Ningbo, China. His PhD examined the political economy of unemployment in order to address interesting questions such as why unemployment is high in some countries and low in others. A number of articles emerged from this study, one of which won him the 2010 JJI Middleton Medal for Best First Article Published in the South African Journal of Economics. His has researched a number of issues regarding the modelling of monetary policy in South Africa and the Eurozone area and looked at issues around the recent debt crisis and fiscal policy in general equilibrium.
He has published in journals such as the European Journal of Political Economy, the International Journal of Forecasting, and Computational Statistics and Data Analysis. More recently he started investigating financial intermediation across both time and states of nature in general equilibrium models. He received a C2 rating from the NRF.

Dr Ochara is a senior lecturer in the Department of Informatics, Faculty of Engineering, Built Environment and Information Technology. His educational background is in business, specifically in management science with its emphasis on the application of scientific and mathematical approaches of operations research to managerial decision making. He holds an MBA in Management Information Systems and a PhD in Information Systems. His current research focuses on the disciplines of operations and information systems, and he is establishing himself as a professional and interdisciplinary researcher in e-government/e-commerce/e-leadership, national information infrastructure (NII) and information. His most recent award was from the NRF (South Africa and Angola) for an ongoing research project titled ‘E-Indaba’ which comprises funding for the development of an e-participation model for digitally excluded groups in Africa. He received a C3 rating from the NRF.
Prof Ochara’s recent publications include the following titles: Ochara, N M, Kandiri, J, & Johnson, R. (In progress.) ‘Influence processes of implementation effectiveness in challenged information technology projects in Africa.’ Information Technology & People; Ochara, N M. 2013. ‘Leadership for the electronic age: towards a development-oriented, socio-technical ontology of leadership’, African Journal of Information and Communications [online]. Available at http:// reference.sabinet.co.za/webx/access/electronic_journals/afjic/afjic_n13_a2.pdf [accessed 4 April 2014]; Ochara, M & Mawela, T. 2013. ‘Enabling social sustainability of e-participation through mobile technology’, Journal of Information Technology for Development, pp 1–24, October [online]. Available at http://reference.sabinet.co.za/ webx/access/electronic_journals/afjic/afjic_n13_a2.pdf [accessed 4 April 2014].




Prof Ogude was appointed professor and research fellow in the Centre for the Advancement of Scholarship in May 2013. His field of specialisation is African literature and cultures.
He heads the research team funded by the Templeton World Charity Foundation to examine the concept and role of ubuntu within and outside the broader intellectual debate on self and community. Previously he was professor of African Literature and Cultures in the School of Literature and Language Studies at the University of the Witwatersrand, where he served inter alia as head of the Department of African Literature and assistant dean for research in the Faculty of Humanities. His research interests include the African novel and the postcolonial experience in Africa, especially in relation to issues of memory and reconstruction of African history and identities, popular cultures and literature in Africa and Black intellectual traditions. He authored Ngugi’s novels and African history: narrating the nation, published by Pluto Press, London in 1999. He co-edited Urban legends, colonial myths: popular culture and literature in East Africa, published by Africa World Press, Trenton in 2007 and, more recently, Rethinking East African literary and intellectual landscapes, published by Africa World Press, New Jersey in 2012. Prof Ogude has also published numerous articles in peer-reviewed journals in the field of African literature and popular culture in East Africa. Prof Ogude received a B3 rating from the NRF.
Prof Steyn is professor at the Graduate School of Technology Management (GSTM) in the Faculty of Engineering, Built Environment and Information Technology. He has been researching various areas related to project management. Recent work was done in the use of computer-mediated communication by project teams, the matrix structure for managing projects, project management maturity, earned value management and projects for human re-settlement. Earlier areas of research included critical chain project management and other applications of the theory of constraints in project environments.
According to Google Scholar (2 December 2013), Prof Steyn’s work has been cited 491 times. He co-authored, with Prof John M Nicholas of Loyola University in Chicago, the textbook titled Project management for engineering, business and technology, the fourth edition of which was published by Routledge in 2012. The book has been translated into, inter alia, Polish and Chinese. Prof Steyn received a C3 rating from the NRF.
Dr Stols is a senior lecturer in the Department of Science, Mathematics and Technology Education in the Faculty of Education. His research intends to bridge the gap between research and practice and involves a systematic enquiry about the conditions under which mathematics teachers use technology for instruction.
Dr Stols did a comprehensive literature study in order to understand the factors that influence the decision by mathematics teachers to use technology in the classroom and presented these results at conferences. He designed a study to examine the influence of mathematics teachers’ beliefs on their intended and actual use of dynamic mathematics software in the classroom. He received a study grant to investigate the geometric cognitive growth of pre-service mathematics teachers in a technology-enriched environment. These results were published in the Australasian Journal of Educational Technology. Dr Stols has published articles on the intersection of the use of technology and geometry. He co-published, with Prof Herman Bernitz, also of UP, articles on the identification of bite marks as evidence in court cases where affine transformations were used to reconstruct distorted bite marks. Articles emanating from this research have been published in the Journal of Forensic Sciences and the International Journal of Legal Medicine. Dr Stols received a C2 rating from the NRF.
Dr Thantsha is a senior lecturer in the Department of Microbiology and Plant Pathology in the Faculty of Natural and Agricultural Sciences. Her research interests are food microbiology and biotechnology, with the focus on the functional and technological aspects of probiotics. She received the WISA Excellence in Water Research Award: Young Researcher Award in 2008. She is currently (from September 2013 to May 2014) on sabbatical as a Fulbright scholar in the Department of Food Science at Purdue University in Indiana, USA. Dr Thantsha received a Y2 rating from the NRF.
Her recent publications include: Thantsha, M S, Labuschagne, P W & Mamvura, C I.2014. ‘Supercritical CO2 interpolymer complex encapsulation improves heat stability of probiotic bifidobacteria’, World Journal of Microbiology and Biotechnology, 30: 479–486. Booyens, J, Labuschagne, M C & Thantsha, M S. 2013. ‘In vitro antibacterial mechanism of action of crude garlic (Allium sativum) clove extract on selected probiotic Bifidobacterium species as revealed by SEM, TEM, and SDS-PAGE analysis’, Probiotics and Antimicrobial Proteins. DOI 10.1007/s12602-013-9145-z. Thantsha, M S, Mamvura, C I & Booyens, J. 2012. ‘Probiotics – what they are, their benefits and challenges’, in T Brzozowski (ed), New advances in the basic and clinical gastroenterology. Croatia: InTech.

Dr Valverde is research fellow at the Centre for Microbial Ecology and Genomics in the Department of Genetics, Faculty of Natural and Agricultural Sciences. He has published more than 40 papers in international scientific journals and a number of book chapters. He was awarded a NRF C2 rating in 2014. Dr Valverde’s research covers different aspects of microbial biodiversity, especially in the fields of taxonomy, phylogenetics and molecular ecology. His main interest is to gain a better understanding of the community ecology and spatial-temporal scaling of microbial taxa and the effects of environmental factors on the distributions of microbial taxa.
His key publications are:
Makhalanyane, T P, Valverde, A, Birkeland, N K, Cary, S G, Tuffin, M I & Cowan, D A. 2013. ‘Evidence for successional development in Antarctic hypolithic bacterial communities’, ISME Journal, 7: 2080–2090; Roychoudhury, A N, Cowan, D, Porter, D & Valverde, A. 2013. ‘Dissimilatory sulphate reduction in hypersaline coastal pans: an integrated microbiological and geochemical study’, Geobiology, 11: 224–233; Valverde, A, Tuffin, M & Cowan, D. 2012. ‘Biogeography of bacterial communities in hot springs: a focus on the actinobacteria’, Extremophiles, 16: 669–679.
Prof Van Aarde is honorary professor in the Department of New Testament Studies in the Faculty of Theology and senior research fellow in the Centre for the Advancement of Scholarship. He obtained an MA degree in Semitic Languages and three doctoral degrees: DLitt (Ancient Languages: Greek), PhD (History of Ancient Culture) and DD (Theology). He has received two awards from the Suid-Afrikaanse Akademie vir Wetenskap en Kuns. From the University of Pretoria he received the Mellon Foundation Mentor Programme Award and five acknowledgements of excellent academic achievement. Prof Van Aarde holds a C1 rating from the NRF.
His recent publications include:
‘The Ebionite perspective in the infancy gospel of Thomas’, in J Schröter (ed), 2013, The apocryphal gospels within the context of early Christian theology Peeters.
‘The tomb cult of the early Jesus-followers in Jerusalem’, in J H Ellens (ed), 2013, Heaven, hell and the afterlife. Praeger.
‘Paul’s version of “turning the other cheek”: rethinking violence and tolerance’, in P de Villiers & J W van Henten (eds), 2012, Coping with violence in the New Testament. Brill.



Prof Van Eck is professor in the Department of New Testament Studies in the Faculty of Theology. His research areas are historical Jesus studies, the gospels, gender studies, sexuality and the Bible and post-colonial readings of biblical texts. His main research focus is the interpretation of the parables of the historical Jesus, using social-scientific criticism as exegetical approach. In using available papyri from the first century, the realism of Jesus’ parables is also investigated. Prof Van Eck uses this approach to read the parables of the historical Jesus as symbols of personal and social transformation. His approach helps the modern interpreter to avoid anachronism and ethnocentrism and consequently yields ‘Jesus values’ that can be applied in a postmodern society.
His article, ‘Interpreting the parables of the Galilean Jesus: a social-scientific approach’, in which he introduced his methodology for interpreting the parables of Jesus, is seen by internationally renowned parable scholars as a new way forward in parable research. In a published article, ‘In the kingdom everybody has enough – a social-scientific and realistic reading of the parable of the lost sheep (Lk 15:4–6)’, he indicates the importance of the use of papyriological evidence in enabling a realistic reading of the parables. As a spinoff of his research on the parables, he developed a social-scientific model for the study of social memory –currently an important topic in historical Jesus research – and presented it in an article titled ‘Social memory and identity: Luke 19:12b–24 and 27’. Prof Van Eck received a C3 rating from the NRF.


Dr Visser is a senior lecturer in the Department of Animal and Wildlife Sciences in the Faculty of Natural and Agricultural Sciences. She specialises in animal breeding and genetics and focuses on the genetic improvement of small-stock, mainly by applying molecular techniques. Dr Visser is the current vice-president of the International Goat Association. She was awarded a bronze medal by the South African Society for Animal Science for her exceptional contribution to the advancement of professionalism and knowledge in animal science. Dr Visser received a Y2 rating from the NRF.
Her recent publications include: Van Marle-Köster, E, Visser, C & Berry, D P. 2013. ‘A review of genomic selection – implications for the South African beef and dairy cattle industries’, South African Journal of Animal Science, 43: 1–17; Visser, C et al. 2013. ‘Quantitative trait loci associated with pre-weaning growth in South African Angora goats’, Small Ruminant Research, 112: 15–20; Qwabe, S O, Van Marle-Köster, E & Visser, C. 2012. ‘Genetic diversity and population structure of the endangered Namaqua Afrikaner sheep’, Tropical Animal Health and Production, DOI 10.1007/s11250-0120250-x.
Dr Vorster is a senior lecturer in the Department of Plant Production and Soil Science in the Faculty of Natural and Agricultural Sciences. He leads the Molecular Plant Physiology Research Group of the Forestry and Agricultural Biotechnology Institute (FABI) and is a member of the Genomics Research Institute. His research centres on the physiology of plant stress, with the focus on the role of the cysteine protease inhibitor system. This research is undertaken in collaboration with scientists from the Université Laval in Quebec, Canada and the University of Leeds, United Kingdom. He is a member of the South African Association of Botanists and serves on the council of the South African Society of Crop Production. Dr Vorster received a Y2 rating from the NRF.

Portraits in this publication by EYEscape Studios and other photographs supplied by Dr Nico de Bruyn, Prof Don Cowan, Prof Wanda Markotter, Prof Jolanda Roux, Prof Bernard Slippers, Prof Rudi van Aarde and other individuals are gratefully acknowledged.
Hiermee gee ons met dank erkenning aan EYEscape Studios vir die portrette in hierdie publikasie, asook aan dr Nico de Bruyn, prof Don Cowan, prof Wanda Markotter, prof Jolanda Roux, prof Bernard Slippers, prof Rudi van Aarde en ander individue vir die foto’s wat hulle verskaf het.
Diswantšho tša ka phatlalatšong ye ka EYEscape Studios le diswantšho tše dingwe di abilwe ke Dr Nico de Bruyn, Prof Don Cowan, Prof Wanda Markotter, Prof Bernard Slippers, Prof Rudi van Aarde le batho ba bangwe ba amogetšwe ka tlotlo. Acknowledgements